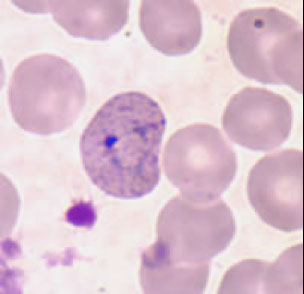
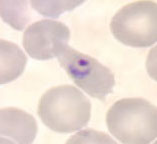
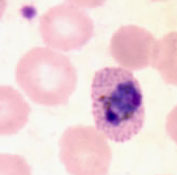
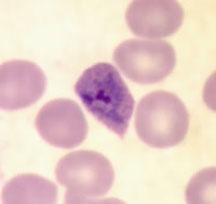
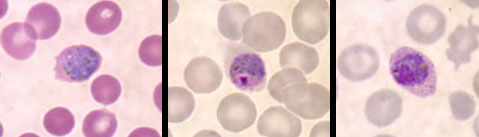
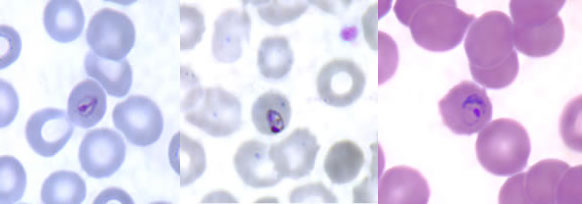

Parasitology
Amebiasis
- General
- Entamoeba histolytica / dispar
- Entamoeba moshkovskii
- Entamoeba coli
- Entamoeba hartmanii
- Entamoeba gingivalis
- Endolimax (Entamoeba) nana
- Entamoeba polecki
- Iodamoeba butsclii
- Naegleria fowleri
- Acanthamoeba spp
- Balamuthia mandrillaris
Flagellates and Ciliates
- Intro
- Giardia intestinalis (G lamblia)
- Dientamoeba fragilis
- Thrichomonas hominis
- Chilomastix mesnili
- Enteromonas hominis
- Retortamonas intestinalis
Hemoflagellates
- Leishmania spp
- Trypanosoma spp
Filarial nematodes (filaria)
- General
- Wucheria bancrofti
-
Brugia malayi
- Brugia timori
- Loa loa
- Onchocerca volvulus
- Mansonella ozzardi
- Mansonella perstans
- Mansonella streptocerca
- Dirofilaria immitis
Malaria
- Plasmodium vivax
- Plasmodium ovale
- Plasmodium malariae
- Plasmodium falciparum
- Plasmodium knowlesi
Babesiosis
Balantidium coli
Protozoa - Apicomplexa
- Cryptosporidium parvum
- Isospora belli (Cystoisospora)
- Cyclospora
- Sarcocystis
Blastocystis hominis
Microsporidia
Toxoplasma gondii
Myxozoa
Nematodes
- Ascaris lumbricoides
- Enterobius vermicularis (pinworm)
- Trichuris trichura (whipworm)
- Hookworm
- Stronglyoides stercoralis (threadworm)
- Trichinella spiralis
- Dracunculus medinensis ("guinea worm")
- Larva migrans
- Capilalariasis
- Anisakiasis
Arthropods
- Ticks, Flies, Lice, Mosquitos, Mites, Hymenoptera, Spiders, Others!!
Cestodes
- Taenia saginata
- Taenia solium
- Hymenolepsis nana (Dwarf tapeworm)
- Diphyllobothrium latum (fish tapeworm)
- Dipylidium caninim
- Echinococcus granulosus
- Sparganosis
Trematodes
- Fasciolopsis buskii
- Heterophyid flukes
- Fasciola hepatica
- Clonorchis sinensis
- Paragonimus westermani
- Schistosoma mansoni
- Schistosoma japonicum
- Schistosoma hematobium
- Schistosome dermatitis



Amebiasis
General
Worldwide distribution, 12% of the world's population infected
(Includes Entamoeba histolytica and E. dispar. Only E.histolytica is considered to be a pathogen, E. dispar is considered a commensal)
● Only10% of infected persons have clinical symptoms, 80-90% of these have diarrhea or dysentery.
● Humans are the major reservoir, acquired by ingestion of food and drink contaminated with E. histolytica cysts
● High risk groups include travelers, immigrants, migrant workers, immunocompromised, persons in mental institutions, and male homosexuals
Entamoeba histolytica / dispar
1. Life Cycle
a) Trophozoites
b) Precyst
c) Cyst
d) Metacyst
e) Metacystic Trophozoite
2. Overview of Life Cycle
● Life cycle is direct with no intermediate host
● Ingestion of cysts (infectious stage) is followed by excystation in either the small or large bowel
● The four nuclei then divide to form eight nuclei (metacystic stage), cytoplasmic division follows and eight amebic trophozoites emerge
● The trophozoite population then resides in the large bowel where tissue invasion may occur
Clinical presentation
Contributing factors; elevated serum cholesterol, low ascorbic acid in diet, high carbohydrate diet, low protein diet, climatic conditions, emotional factors, genetic factors, absence of previous exposure
- Certain zymodemes of Entamoeba histolytica may be pathogenic while others are not
- Isoenzyme analysis: glucophosphate isomerase, phosphoglucomutase, malate dehydrogenase, hexokinase
- All isolates fall into two groups considered "invasive" and “noninvasive".
The noninvasive (nonpathogenic) strains are now considered a separate species called Entamoeba dispar.
● The name Entamoeba histolytica is retained for the invasive (pathogenic) form.
● The two species are indistinguishable based only on microscopic morphology.
● May also be an ameba-bacterium association
1. Asymptomatic Cases
● Negative or weak Ab titer, no occult blood in stools, trophozoites if detected do not contain RBC's
● Many never become symptomatic and only excrete cysts for a short time.
● The assumption here is that these individuals are infected with Entamoeba dispar
2. Symptomatic Cases: Entamoeba histolytica
● E. histolytica is unique among the intestinal amoeba parasitizing humans because it is able to invade tissue
Intestinal: pathology usually seen in cecal area
● Mucosal lesions form a characteristic early flask-shaped or teardrop-shaped ulcer
- In acute amebiasis (amebic dysentery) abdominal discomfort and tenderness is present and patient passes numerous dysenteric stools
- In subacute amebiasis similar symptoms are present but are less dramatic
- In chronic amebiasis most patients are without distinctive signs or symptoms but may have periodic bouts of diarrhea alternating with constipation
Extra-Intestinal Amebiasis: result of previous intestinal infection
- Liver abcesses can occur concurrently with colitis or there may be no clinical history of E. histolytica intestinal infection
● Onset may be acute with abdominal pain and fever or subacute with weight loss
● Liver abcesses seen more frequently in adults than in children, and are filled c anchovy paste
● Other sites rarely affected (pulmonary, brain, pericardium, spleen)
Dx
Troph nucleus is key for dx and has small, central karyosome c even dots of heterochromotin along inner nuclear membrane
- Cytoplasm can have ingested RBC's
Has Unidirectional motility on wet mount
- cysts have no more than 4 nuclei and smooth rounded ends
Serologic tests have been useful in these cases (IHA, IF, Latex Agglutination, CIE, Immunodiffusion, and ELISA)
Tx
Metronidazole, Chloroquine, Dehydroemetine
- This should be combined with a poorly absorbed luminal amebacide for clearing the bowel of E. histolytica (Iodoquinol, Diloxamide, furoate)
Entamoeba moshkovskii
Free- living amoeba that has been found in Bangladeshi kids and people in India, usually in a mix c E dispar and possibly E histolytica
- could possibly be pathogenic, but most monoinfections are asymptomatic
Similar morphology to E histolytica and E diaspar
- originally found in sewers of Moscow by PCR and zymodeme analysis of cultured organisms
-- idnetical to Laredo strain of E histolytica
Entamoeba coli
Nondirectional motility, eccentric karyosome, irreg clumped nuclear chromatin, frayed chromatoidal bodies, 8 nuclei in cyst formation and does not ingest RBCs
Entamoeba hartmanii
Bears close resemblance to E. histolytica (central karyosome c nuclear chromatin finely beaded alond nuclear membrane), but smaller and does not ingest RBCs
Entamoeba gingivalis
Seen in pockets bwt teeth and gums in tonsillar crypts
- can ingest WBCs
- no cyst form
Endolimax (Entamoeba) nana
Large, knobby "ball and socket" central karyosome
- cyst form has same nuclei, but no chromatoidal bodies
Entamoeba polecki
Found in kids in Papua New Guinea, and in pigs and monkeys there too
Iodamoeba butschlii
True to name, has prominent glycogen vacuole in cyst form that stains c iodine
- like E nana, has large "ball-and-socket" central karyosome
Naegleria fowleri
Sx
● Causes an acute and fulminating primary amebic meningo- encephalitis (PAM) which generally produces death in 5-7 days
● Symptoms include headache, fever, nausea, vomiting, signs of meningitis develop, then coma and death
● Organisms enter the nasal passages of persons swimming in warm lakes and streams and make their way into the frontal lobes of the brain via cribriform plate
Dx
Trophozoites seen on direct examination of CSF as a wet-mount preparation is the principal means of diagnosing PAM
- Amebae if present, are detected by their active directional movement
- only ameboid trophs are in tissue and multiply by binary fission
● Culture can also be attempted on agar plates precoated with "lawn" of bacteria (E coli), which it ingests and leaves a trail
Tx
● Treatment is usually unsuccessful but amphoteracin B and sulfadiazine have been effective in a few cases
● Early diagnosis and immediate treatment is crucial
Acanthamoeba spp.
Sx
Causes a more chronic form of meningoencephalitis called Granulomatous amebic encephalitis (GAE)
- Granulomatous lesions in the brain. Onset is slow and may last for months before causing death
● Infected patients may be immunocompromised
- Also reported to cause keratitis due to contaminated contact lens solutions
Dx
● Granulomatous lesions in the brain may contain both cysts and trophozoites
● Have also been found in lungs, nasal passages, eyes, skin lesions, vagina, and even stool samples
● Demonstration of the organism in CSF and tissue samples as for Naegleria
● Nine species of Acanthamoeba, Balamuthia, and Hartmannella have been involved in human infections
● Culture can also be attempted
Tx
● Treatment is speculative but ketoconazole, together with topical miconazole may be useful in cases of keratitis
● Amphoteracin B and sulfadiazine for meningoencephalitis
Balamuthia mandrillaris
● May cause granulomatous amebic encephalitis (GAE)
● Can be transmitted through solid organ transplants
- Hispanics may be more susceptible
● Very rare but usually fatal
● First identified in 1986 from the brain of a baboon
● ≈ 200 cases worldwide, 70 in the U.S.
● Sappinia diploidea, Hartmanella spp., Vahlkampfia spp.
Flagellates and Ciliates
Four common species of intestinal flagellates; Giardia intestinalis, Chilomastix mesnili, Trichomonas hominis, and Dientamoeba fragilis.
● In addition, there are two small flagellates that are sometimes encountered in stool samples; Enteromonas hominis and Retortamonas intestinalis.
● Only Giardia intestinalis and Dientamoeba fragilis can cause disease.
● A pathogenic trichomonad, Trichomonas vaginalis occurs in the urogenital tract and the commensal Trichomonas tenax is found in the mouth.
● Balantidium coli is a ciliated protozoan and the only member of its phylum to parasitize humans.
● The flagellates other than Dientamoeba are readily recognized by their characteristic motility and the three larger species can be identified in unstained wet mounts.
Axoneme = intracellular part of flagellum
Axostyle = axial rod with supportive function in flagellates
Blepharoplast = basal body origin of flagella that supports undulating membrane
Undulating membrane = finlike structure connected to outer edge of some flagellates
Median bodies = comma-shaped structures in the posterior part of Giardia intestinalis
Giardia duodenalis (intestinalis or lamblia)
MC intestinal parasite in the U.S.
- flagellated protozoan and the only common protozoan found in the duodenum and jejunum of humans.
Trophozoite
● Described as kite-shaped or pear-shaped, bilaterally symmetrical, with central axostyle running along its length
● Possesses two nuclei in the trophic form, "falling leaf" motility
● Trophs have four pairs of flagella, a sucking disk, median bodies, and axonemes
● Nuclei are spherical or ovoid & contain a large central karosome with no peripheral chromatin
Cyst
● Cysts are ovoid with four prominent nuclei & four median bodies that cluster around axostyle
● Cysts contain twice the number of intracytoplasmic flagellar structures as seen in the troph (all dispersed in random fashion)
● Cyst wall is smooth and colorless and usually set off from the cytoplasm
Life Cycle
● Infection acquired by ingestion of mature quadrinucleate cysts
● Cyst wall is removed by digestive juices in the small intestine and the organism quickly differentiates into two binucleate trophozoites
● Trophs attach to epithelial cells in the crypts of the doudenum and upper jejunum by their sucking disk
● Cyst formation is initiated when trophozoites are displaced from their site of attachment and carried into the large intestine
Epidemiology
● Worldwide distribution, prevalence varies from 1.5% to 20% or higher
● Occurs in epidemic proportion when water supplies become contaminated with infective cysts (fecal-oral)
● Animals, especially dogs and beavers, may be reservoirs
● Cysts remain viable for three months in water & are resistant to usual levels of chlorine used in water purification plants
● Outbreaks among children in day care centers have been reported and in hikers
● Children are more susceptible and have more severe infections
● Malnutrition, achlorhydria, or hypogammaglobulinemia predispose to infection and more severe chronic infections
Sx
● Clinical presentation varies greatly from person to person
● Little correlation between magnitude of parasite burden and severity of illness
● 50% or more of Giardia infections are asymptomatic
● Symptoms include severe diarrhea, foul-smelling greasy mucous-laden stools (steatorrhea), flatulence, epigastric pain, nausea, anorexia, abdominal cramps
Dx
Wet mount shows cysts (oval c 4 nuclei around central axostyle) or trophs (pear/kite-shaped c 2 nuclei) in fecal specimens - "falling leaf" motility
- look spoon-shaped from the side
May recover trophs directly from the small intestine (duodenal biopsy, intubation, aspiration of duodenal contents)
● Entero-Test can also be used (less invasive technique) - like fishing for organisms with capsule
● Permanent stains are more reliable than wet mounts
● ELISA tests and Immunofluorescence tests are available commercially
Tx
● Quinacrine hydrochloride (Atabrine) is effective as well as Metronidazole (Flagyl)
● Precautions for the prevention of amebiasis are applicable to Giardiasis
● Municipal watersheds should be protected from exposure to animals
● Water purification kits for backpackers should use iodine for the greatest effectiveness
Dientamoeba fragilis
Intro
● Ameba-like structure and progressive motility by "pseudopods"
● No cyst stage and up to 80% of trophs are binucleate (hence di-entamoeba)
● Studies using electron microscopy determined that Dientamoeba fragilis is actually a flagellate and is classified with the trichomonads
Trophozoites
● Pseudopodia are hyaline, broad, leaf-like in appearance with characteristic serrated edges or margins with 2 nuclei and "fractured" karyosome
● Motility is progressive & the organisms are very active in freshly passed stools
● On cooling however, they round up quickly
● Unstained, the organisms are inconspicuous and nuclei are not visible; can have ingested RBCs
● When stained, Dientamoeba is identified on the basis of a high % of binucleate forms and the typical nuclear structure
● Nuclear membrane is delicate, no peripheral chromatin, in the center of the nucleus is a large mass composed of 4-8 separate chromatin granules (usually arranged symmetrically)
Life Cycle
● Dientamoeba lives in mucosal crypts of the large intestine and has been seen rarely to ingest red blood cells
● The organism never invades the tissues
● Trophs multiply asexually by binary fission in the cecum of the large intestine
● Since there is no cyst stage, it is passed in the feces as a trophozoite
● The binucleate trophs are both the diagnostic stage and the infective stage
Epidemiology
● Mode of infection is uncertain but probably involves hand/mouth transfer from infective individuals or fecally contaminated sources
● One hypothesis is that the trophs are carried into the body within the eggs of Enterobius vermicularis (coinfection is common)
● Prevalence ranges from <1.5% to nearly 20% but may be higher among institutionalized persons
● Detection of Dientamoeba is best accomplished when stool specimens are preserved in PVA fixative immediately after passage.
Sx
● 15-27% of infected persons are symptomatic
● Abdominal pain and diarrhea are the most prominent symptoms
● Also; bloody, mucoid, or loose stools, flatulence, fatigue, weakness, alternating periods of diarrhea and constipation (***hence, di-symtpomatic***), nausea, weight loss, vomiting
Dx
● Unstained trophozoites are not characteristic
● Stained trophozoites are diagnostic
● Diagnostic criteria include a high % of binucleate trophozoites
● Characteristic nuclei are without peripheral chromatin and have 4-8 chromatin granules arranged in a central mass
Tx
● Iodoquinol is usually effective and tetracycline can be used as an alternative
● Paromomycin (humatin) is an aminoglycoside used to treat cases that do not respond to Iodoquinol or tetracycline
Trichomonas hominis
Non-pathogenic for humans but presence of the organism is indicative of direct fecal contamination
- Living trophozoites are 7-15μm long and move about very rapidly with a jerky, nondirectional motion
- The organism does not have a cyst stage
- nucleus at anterior end of axostyle
The organism has four anterior flagella plus a recurrent flagellum that forms the outer edge of the undulating membrane
- The undulating membrane joins the body along a line marked by a thin curved rod called the costa
- The costa is about the same length as the undulating membrane and is an important diagnostic characteristic
● The recurrent flagellum projects behind the body as a free flagellum
● The single nucleus is found at the anterior end of the body and its chromatin is unevenly distributed, with a small karyosome
● The axostyle is a sharply pointed slender rod that protrudes beyond the posterior end. (the axostyle is diagnostic)
● No other intestinal protozoan possesses a costa - it is diagnostic
*** this man (hominis) has sailed up the coast (costa) from the vagina***
Chilomastix mesnili
Not pathogenic to humans but it must be differentiated from Giardia and other flagellates
Trophozoites:
● Trophs are elongate and taper toward the posterior end
● 10-20μm, have three flagella at the anterior end, and a single nucleus.
● In fresh specimens, the flagella can be seen as well as a groove running in a spiral along the length of the body
● The cytostome (oral depression) is bordered by cytostomal fibrils
● The most prominent cytostomal fibril curves posteriorly around the cytostome and resembles a "sherherd's crook" (looks like a safety-pin)
● Nuclear chromatin may appear as granules and sometimes there is a small central or eccentric karyosome
Cysts:
● At the anterior pole of the cyst is a nipple-like protuberance that gives it a characteristic "lemon shape" with anterior knob
● Cysts are 6-10μm in length
● There is a single large nucleus with the chromatin frequently condensed to appear as a large central karyosome, which is next to the safety pin
● The curved cytostomal fibrils are usually quite prominent and can be seen even in iodine preps
● With hematoxylin, the recurrent flagellum can be seen between the cytoplasm and the cyst wall at the anterior end
Enteromonas hominis
● A small, rarely encountered intestinal flagellate, 4-10μm long
Trophozoite:
● Body is broadly oval anteriorly & somewhat attenuated posteriorly
● Three anterior flagella provide for rapid jerky motion
● The fourth flagellum is directed posteriorly
● In living specimens little can be observed other than general shape, flagellar movement, and the trailing flagellum
● In stained preps, a single nucleus is seen near the anterior end with a distinct nuclear membrane and large central karyosome and no peripheral chromatin
Cyst:
● Usually inconspicuous, ellipsoid, and 6-8μm long
● Unstained cysts look very much like yeast cells
● Stained cysts show one to four nuclei with same structure as in the troph. Most have two nuclei
● Cysts are about the same shape as those of Endolimax nana and the size range overlaps
● A predominance of binucleate cysts of small size is highly suggestive of Enteromonas hominis
Retortamonas intestinalis
● Another small, infrequently seen intestinal flagellate
Trophozoite:
● Ovoid or tear-shaped, move rapidly by means of two anterior flagella
● Body length ranges from 4-10μm and a cytostome extends from near the anterior end to about half the length of the organism
● It is sometimes possible to see the two anterior flagella and cytostome in unstained preps
● Stained preps show a relatively large nucleus at the anterior end
● The nucleus contains a small, compact central karyosome with a layer of fine chromatin granules on the nuclear membrane
● A fibril borders the cytostome but does not have the "shepherds crook" characteristic of Chilomastix
Cyst:
● Pear-shaped cysts are 4-7μm long with a single relatively large nucleus frequently near the center
● Two fibrils extend from the nuclear region to the attenuated end of the cyst
● This fibrillar arrangement is suggestive of a "birds beak" and is characteristic
● Unstained cysts are difficult or impossible to identify
EXTRAINTESTINAL FLAGELLATES
Trichomonas vaginalis
Life Cycle
● Trichomonas vaginalis exists only in a trophozoite stage and has an axostyle and an undulating membrane and 2 nuclei at anterior end of axostyle
● It is the only trichomonad known to inhabit the human urogenital tract
● Infections are usually acquired when the trophozoite is passed to an uninfected sexual partner during intercourse
● In the urogenital tract the organisms multiply and establish colonies on the surface of epithelial cells
Epidemiology
● Prevalent in sexually active age groups (sexually transmitted disease)
● Prevalence rate varies from 5% in males to 50% in females in some populations
● Newborn girls are at special risk of acquiring trichomoniasis from an infected mother during birth (respiratory disease & conjunctivitis)
● Person to person transmission may occur where there is a lack of proper toilet / bathing facilities, or by sharing of clothing or washcloths
Sx
● Trichomonas infections in males are usually asymptomatic but involvement of the prostate or seminal vesicles, or secondary bacterial infection may lead to clinical symptoms
● Males may have a thin urethral discharge, dysuria, nocturia, groin pain, and enlarged prostate
● In females the severity of disease varies from mild vaginal itching to an intense burning
● Females may have frequency of urination, dysuria, and a thick yellow discharge
● Severe dermatitis of the inner thighs is a result of constant scratching
● A relationship between this infection and cervical carcinoma has been suggested
Dx
● Lab diagnosis is based on finding the characteristic motile trophozoites in vaginal or urethral discharges
● No other species of trichomonad are routinely found in the urogenital tract and stained preps are rarely necessary
● The organism has a characteristic jerky nondirectional motility which is easily recognizable
● Trichomonas vaginalis is often detected during routine urinalysis
Trichomonas tenax
● Trichomonas tenax resembles T. vaginalis more closely than T. hominis (has also been called T. buccalis)
● It is a small organism averaging only 6-10μm in length
● Occurs most frequently in pyorrheal pockets and tonsillar crypts
● It is sometimes aspirated to set up a transitory bronchial or pulmonary infection
● 16% of dental patients in clinical practice carry oral Trichomonas tenax
● In pulmonary trichomoniasis the only treatment necessary is directed at the underlying condition, if any
THE CILIATE/S
Balantidium coli
Life Cycle
● The life cycle of Balantidium coli is very similar to that of Entamoeba histolytica
● The organism is infective for humans in the cyst stage
● It is the only member of its phylum to parasitize humans (also the only ciliated parasite of humans)
● The organisms inhabit the large intestine, cecum, and terminal ileum
● They are chiefly lumen dwellers, subsisting on bacteria, but may penetrate the intestinal mucosa to cause ulceration
Epidemiology
● Infections occur worldwide but are apparently rare
● Most cases have been reported from tropical and subtropical regions
● In temperate climates crowding or poor personal hygiene, as in mental institutions or prisons, seems to be a factor favoring infection
● Close contact with animal species that harbor Balantidium spp. can result in human infection (especially pigs & monkeys)
● Except in humans and lower primates, the organisms do not appear to cause disease
● Efforts to transmit the infection from animals to humans have not been successful
● Balantidiasis is more common in persons closely associated with pigs
Sx
● Most infections with Balantidium coli are asymptomatic
● In some individuals, the organisms begin to feed on host cells of the intestinal mucosa
● With the aid of hyaluronidase, the organism can burrow into the submucosa of the large intestine producing flask-shaped ulcers similar to those seen with Entamoeba histolytica
● Clinical symptoms: intermittent periods of diarrhea and constipation, dysentery, abdominal pain, nausea, and vomiting
● Toxic manifestations: fever, headache, and insomnia
Dx
● Balantidium coli is easily identified due to its large size and the characteristic boring motility of the trophozoite
● The organism can easily be identified simply by use of wet mounts
● A wet mount is the preferred method of examination as the trophozoite is the predominant diagnostic stage in most clinically manifest infections.
Trophozoite:
● The trophozoite is covered by rows of tiny cilia and measures 30-120μm in length
● Typically the troph is round to oblong with a slightly pointed anterior end and a rounded posterior
● At the anterior end is a V-shaped groove that constitutes the organisms cytopharynx and cytostome
● The organism moves forward with a boring type of motility and food material is swept into this cleft
● The trophozoite of Balantidium coli contains two contractile vacuoles and two separate nuclei
● The sausage-shaped macronucleus and the tiny micronucleus each have separate cellular functions
Cyst:
● The cysts are typically round and much larger than those of other intestinal protozoa
● They measure 50 to 70μm in diameter
● Each cyst contains a single organism which in the early stages may still have active cilia
● As the cyst matures, the cilia disappear
Hemoflagellates
INTRODUCTION
● Leishmania spp. and Trypanosoma spp. are referred to as the "Hemoflagellates"
● They are in the order Kinetoplastida, characterized by a kinetoplast (an accessory body seen in lots of protozoa made of a large mitochondrian next to the basal granule of the anterior or undulating membrane flagellum)
● They are spread by arthropod hosts and have animal reservoirs (dogs, cats, rodents, etc.)
MORPHOLOGIC STAGES
● Four primary stages in the life cycle of the organisms
1. Amastigote: 2-5μm, nucleus, kinetoplast, axoneme, no flagellum, intracellular
2. Promastigote: slender, elongated, central nucleus, anterior kinetoplast, axoneme, has a flagellum
3. Epimastigote: similar to promastigote but kinetoplast is closer to the nucleus and it has a small undulating membrane with axoneme, anterior flagellum
4. Trypomastigote: kinetoplast at posterior end, undulating membrane with axoneme extending the length of the organism, emerging as an anterior flagellum
● Amastigotes and Trypomastigotes are most common forms seen in humans
● Other forms found primarily in arthropod vectors
Leishmania
Disease caused by Leishmania spp. which parasitize monocytes & macrophages as amastigotes (with bar-like kinetoplast) in humans and live as obligate intracellular parasites
Amastigotes are found in humans & promastigotes are found in the arthropod vectors
- Promastigote virulence caused by:
1) Lipophosphoglycan, which activates complement and inhibits complement action
2) Gp63 cleaves complement and attaches to macrophages
Some proliferate at 37°C and cause visceral leishmaniasis
● Others prefer lower temperatures and cause cutaneous or mucocutaneous leishmaniasis
● Infection spread by sandflies Phlebotomus (Old World) & Lutzomyia (New World)
● Epidemiology, clinical manifestations, and species of Leishmania differ
● Host factors are important, immunocompromised hosts may develop severe disease
*** the Major wanted to go to the tropics, Mexico and Brasil, but when he got to Brazil he Chugged (Chagas) something made by Baby Infant Donovani that made him sick to his marrow*** (keeps getting deeper - Cutaneous: Major, Tropica, Mexicana, Brazilensis; Mucocutaneous: Brazilenesis; Visceral: Infantum, Donovani, Chagasi)
Cutaneous Leishmaniasis (Oriental sore)
Caused by Leishmania tropica complex
- Leishmania major, L. tropica, or L. aethiopica in the Old World (Mediterranian, Middle east, Central Africa)
- Referred to as “Oriental Sore”
Transmitted via sandflies (Phlebotomus)
Chronic disease, may last for a year or longer
Caused by L. mexicana complex or L. braziliensis complex , in the New World (Central & South America)
● “Chiclero ulcer” or “Bay sore” in the new world
● Sandflies of the genera Lutzomia and Psychodopygus are vectors
● Clinical disease varies depending on the species of Leishmania causing cutaneous leishmaniasi
Mucocutaneous Leishmaniasis
Caused by Leishmania braziliensis complex in the New World and L. tropica & L. major in the Old World
● Cutaneous lesions develop as in cutaneous Leishmaniasis but are frequently multiple and may become large
● Secondary infection plays a prominent role
● Progress is slow but steady and may involve the entire nasal mucosa and the hard and soft palates
● The nasal septum is destroyed and ulceration may result in loss of all soft parts of the nose, lips, etc.
● Death usually occurs from secondary infection
Visceral Leishmaniasis (Kala-azar)
Caused by L. donovani complex in the Old World
and L. infantum chagasi in South & Central America
- Amastigotes proliferate in cells of the R.E. system
- Dz in liver, spleen, lymph nodes, bone marrow
● Many patients have mild sx or asymptomatic, but some have severe or fatal disease when untreated
● Vectors are various species of sandfly
● Onset is gradual and clinical presentation varies with different geographical areas and species of Leishmania involved
● Reservoir hosts also vary
● Clinical picture may mimic many other diseases and includes skin lesions, fevers, and most notably abdominal enlargement due to hepatomegaly and splenomegaly.
Dx
In tissue sections or impression smears the amastigote is identified by presence of darkly staining kinetoplast & a lighter staining nucleus and is PAS negative
- Presence of a kinetoplast aids in differentiating amastigotes from Histoplasma, Toxoplasma, or Sarcocystis sp.
- L. donovani usually diagnosed from liver, spleen, bone marrow, lymph nodes
Culture of promastigotes from blood or buffy coat (systemic forms) or of aspirates or skin scrapings (cutaneous forms) is definitive and more senditive than visual detection (done on Novy-MacNeal-Nicolle medium, look for promastigote)
- Montenegro test is a skin test (intracutaneous injection of leishmanin) use in epidemiological surveys of high-risk populations, which is a delayed-type hypersensitivity rxn and pos result indicative for cutaneous and mucocutaneous leishmaniasis (negative in diffuse cutaneous or visceral leishmania
● Serologic tests may be helpful in diagnosing visceral leishmaniasis
Trypanasoma spp
Tryptomastigotes may be found in the blood at some time during disease process
- Neither American trypanosomiasis (Chagas' disease) nor African trypanosomiasis (Sleeping sickness) is a major concern in the U.S.
or other developed countries
- Most all human cases in U.S. are imported though occasional cases of Chagas' disease may occur in the Southern U.S.
- Trypanosomes known to cause human disease include Trypanosoma cruzi, T. brucei gambiense, and T. brucei rhodesiense
Chagas disease
Caused by Trypanosoma cruzi , requires both an animal reservoir (rodent) and an insect vector (reduviid "kissing" bug) and is a leading cause of heart failure in Central and South America and causes achalasia
- Both vector & animal reservoir are found in an area extending from Georgia to California (some cases occur in lifelong residents of the U.S.)
- may be spread by blood transfusion
Infectious forms are shed in feces of the triatomine (reduviid, kissing) bug and are rubbed into the bite wound, causing a local lesion (chagoma)
- Amastigote stage proliferates in organs such as the heart
- Trypomastigotes may be present in peripheral blood early in disease
Disease usually resolves w/o treatment but can be fatal in children
- More chronic sequalae may develop years after initial infection and can lead to death (myocardial defects, myocardial scarring, megacolon, megaesophagus)
Dx
● In Chagas' disease, trypomastigotes may be found in the peripheral blood early in the disease
● Later, amastigote forms can be seen on histologic exam of affected organs (heart)
● Culture of peripheral blood is diagnostic when positive (Novy-MacNeal-Nicolle [NNN] medium)
● Trypomastigotes of T. cruzi are typically less sinuous than those of the African trypanosomes and have a large kinetoplast
● The trypomastigotes typically are seen in a “C” shape - ***"C" for Cruzi and Chagas***
● Diagnosis however is usually established by serologic testing
African Trypanosomiasis
Transmission to humans requires tsetse flies (Glossina spp) which is limited to Africa
- Reservoir is primarily in humans in West Africa (T. brucei gambiense ) and in animals in East Africa (T. brucei rhodesiense )
Triphasic dz:
1. Chancre at site of bite
2. Hemolymphatic stage (fever, lymphadenopathy)
4. "Sleeping sickness" c CNS dz (somnolence, meningoencephalitis, headache)
African trypanosomes covered in Variant Surface Glycoprotein (VSG), which is targeted by host c Abs, thus killing most trypanosomes and causing fever, though some survive by altering their VSG protein, and eventually make it to the CNS
T. brucei rhodesiense limited to E and SE Africa, but classically produces septicemic disease with generalized lymphadenopathy & may cause a fatal encephalitis within a few months ***hit the Rhode***
- T. brucei gambiense is more widespread and is indolent, rarely producing encephalitis (sleeping sickness) in less than 2-3 yrs.
Dx
African Sleeping Sickness
- In contrast to T. cruzi , the African trypanosomes remain extracellular as trypomastigotes and proliferate in that stage
- They are more sinuous and have a kinetoplast smaller that that of T. cruzi
- They circulate in peripheral blood acutely and may be seen in biopsies or aspirates of involved lymph nodes as well as in blood marrow
- Late in disease trypomastigotes may be found in CSF (Giemsa stain)
- Mott cells - plasma cells filed c cytoplasmic globules containing Igs in the






Enamoeba life cycle

Entamoeba cysts
Trophozoites eating RBCs






Ameboid, cysts and flagellate forms

Acanthamoebic keratitis







K = karyosome, Nu = nucleus, MB = median body, Ax = axoneme, CW = cell wall







Trichomonas hominis
Fg=flagellum, bb=basal bodies, um=undulating membrane, nu=nucleus, cy=cytostome, ax=axostyle, cs=costa www.tulane.edu/~wiser/protozoology/notes/intes.html#Df











Retortamonas intestinalis trophozoite and cyst














Amastigote

Trypomastigote


Phlebotomus and Lutzomyia sandflies


Amastigote
Promastigote



Oriental sore



Extreme splenomegaly

Leishmania lifecycle



ROMAÑA’S SIGN

Megacolon in chronic Chagas disease


Chagas disease: amastigotes in heart and trypomastigotes in peripheral blood


Winterbottom's sign: enlarged posterior cervical LNs

Trypomastigotes in PB



Entamoeba coli cyst

Iodamoeba butsclii cyst
Filiarial nematodes (Filaria)
Phylum--> Nemathelminthes ---- Class----> Nematoda
● Commonly referred to as the Filaria
General
The filarial worms are arthropod-transmitted parasites of the lymphatic, subcutaneous, and cutaneous tissues of humans
Lymphatic: Wuchereria, Brugia (malayi and timori)
- both are also spread by mosquito and affect the lymphatics, causing elephantiasis
Cutaneous: Loa loa, onchocerca, Mansonella streptocerca
Body cavity: Mansonella (perstans and ozzardi)
The female adult worm produces a primitive larva called a microfilaria which is found in the peripheral blood or in the skin
Some species of microfilariae circulate in the blood with a well- defined circadian rhythm or periodicity (can be nocturnal or diurnal)
-Other species lack periodicity and circulate at all hours
Adult worms are typically sequestered in the tissues
Laboratory diagnosis of filariasis
Knowing the periodicity of the filarial diseases will generally determine the best time to obtain blood samples for demonstration of microfilariae
- Evidence indicates the periodicity is dependent on the corresponding vector's feeding schedule
- Primary method of filariae diagnosis is microscopic examination of the microfilaria in stained preparations of blood or of a tissue scraping of an infected nodule
Microfilariae detected in samples of blood by a variety of techniques
- Microfilaria can be recognized by their size and rapid movement in thick wet blood films but individual species identification cannot normally be made
- Thick blood films stained with Giemsa or hematoxylin are usually necessary to distinguish the morphological features of each species.
Often the number of microfilariae in the blood may be too few to find even in thick films so that larger volumes of blood must be examined
Generally, microfilariae are identified on basis of size, presence or absence of a sheath, staining characteristics with Giemsa, and the structure of the tail
- Noting the specimen source is helpful in determining which organisms and morphologic forms may be found
Mansonella perstans and Oncocerca volvulus have no sheath, periodicity, not seen in the blood
(***MO PBS [periodicity blood, sheath]***)
Wucheria bancrofti and O volvulus have no tail nuclei (***WO tail nuclei***)
***W after M as T(tail) after S(heath)***
Dx
Must find microfilariae in the blood or skin
- Microfilariae are veriform in shape & appear to be composed of a column of nuclei
- Some species are enveloped in a sheath, some have no sheath
Tx
Diethylcarbamazine (DEC) and invermectin (Mectizan) commonly used
- Surgical intervention is sometimes indicated
- Control measures include personal protection from the vectors when entering endemic areas as well as the destruction of breeding areas and use of insecticides when appropriate
Wuchereria Bancrofti
Cause bancroftian filariasis, MCC filaria in humans
- Adults who were exposed to W. bancrofti as children may become infected and experience no symptoms.
Asymptomatic infection
- Found in tropical & subtropical areas of the world
- Culex, Aedes, and Anopheles species of mosquitoes serve as the intermediate hosts and vectors of W. bancrofti.
- Adult worms live in the host's lymphatic system and produce lymphangitis, lymphadenitis, and obstructive fibrosis
- Chronic infection may result in elephantiasis of extremities & genitalia
Microfilaria circulate in the peripheral blood with a nocturnal periodicity
- In the South Pacific the microfilaria is essentially w/o periodicity
Histo
Microfilariae are sheathed, c smooth curves
- Column nuclei are dispersed; there is a short head space and the pointed tail is devoid of nuclei.
- Light staining of sheath to no staining at all with Giemsa
- must distinguish microfilariae of w. bancrofti from other sheathed microfilaria
- Microfilariae may be present only in small numbers so sensitive procedures must be used (thick blood films, Knott concentration, membrane filter conc.)
Brugia malayi
Mosquito-borne filaria which inhabits the lymphatic system of humans and cause Malayan Filariasis
- Anopheles, Aedes, Armigeres, and Mansonia sp. of mosquitoes serve as vectors and intermediate hosts
- Geographically restricted to Asia and India.
- In some areas it is coendemic with W. bancrofti
Sx
Pathology is similar to that produced in bancroftian filariasis in chronic infections, although it prefers to cause elephantiasis of the legs
- Microfilaria circulate in the blood and may be periodic or subperiodic, but generally, B. malayi exhibits nocturnal periodicity
Histo
Similar in structure to W. bancrofti microfilaria being sheathed but somewhat smaller
- also differs from W. bancrofti in that there are terminal and subterminal nuclei in the tail
- Characteristically there are two distinct nuclei at the tip of the tail
- Also the sheath stains a bright pink color with Giemsa stain
Brugia timori
Another Brugia spp. Brugia timori was first reported from the island of Timor (Indonesia) in 1964.
- humans are the only host
- microfilariae have a nocturnal periodicity
Sx
Similar to bancroftian filariasis, however tyically see elephantiasis of the legs as well as abscess formation
Histo
The microfilariae are somewhat longer than those of B.malayi
- nuclei go to the tip of the tail and the sheath does not stain c Giemsa
Loa loa
A common filarial parasite of humans endemic only in West & Central Africa
- Human infection initiated by the bite of an infected Chrysops fly (deer fly)
Sx
Often called the eye worm because the adult worms often migrate into the conjunctiva and the cornea of the eye (***the 2 O's of lOa lOa are eyes***)
- Adult worms move freely through the tissues, producing transient inflammatory reactions referred to as "calabar swellings"
- Microfilariae circulate in the blood, often in large numbers with a diurnal periodicity
-- microfilariae are not present in blood until years after infx
Histo
Microfilariae are sheathed and measure up to 300μm in length
- Compared to other sheathed microfilaria, nuclei extend to the end of the tapered tail and are arranged irregularly along it's length
- sheath does not normally stain with Giemsa stain
Dx
Finding the microfilaria in diurnal blood films
Tx
Surgical removal of adult Loa loa worms is the treatment of choice, ideally when they are attempting to cross the eye and/or the bridge of the nose
Onchocerca volvulus
Causes River Blindness
Occurs across Central Africa, Yemen, Mexico, portions of Central & South America
- Vector: blackfly genus Simulium is responsible for transmission of O. vulvulus
Sx
Adult worms embed in fibrous nodules in the subcutaneous and sometimes deeper tissues
- These nodules are called "onchocercomata" and may be found on the head, trunk, and extremities
- can cause ocular sx
- anatomic allocation frequently correlates with the geographical strain of the parasite
Histo
Microfilariae in the skin (not blood), have no sheath
- The tail is tapered, usually bent or flexed, and without nuclei
- The microfilaria is rarely found in blood but can sometimes be found there as well as in urine after treatment.
Dx
Finding the typical microfilariae in skin snips teased in water or saline (also in fluid expressed from scarified skin or in aspirates from nodules)
- Adult worms may be demonstrated in excised nodules which have been sectioned and stained
- Adult worms may be freed from the fibrous tissues of the nodule by using digestive enzymes such as collagenase
- Teasing the skin snips liberates the microfilariae from the tissues
Mansonella Species
Mansonella ozzardi
North & Central America and in parts of the West Indies
Vectors: Culicoides sucking midge flies or
Simulium blackflies, depending on the geographic location.
- Both vectors are so small that they are not detained by nets or screening equipment
Sx
Emerging adults take up residence in body cavities, visceral fat, and mesenteries.
- Asymptomatic infections are common
- Symptomatic cases are characterized by eosiniphilia, urtcaria, lmyphadenitis,
skin itching, and arthralgias.
Histo
Microfilaria have a rounded, blunt anterior end and measure about 88μm
- Posterior end is short and not as tapered as that of O. vulvulus
- The organism contains numerous nuclei that do not extend to the tip of the tail
- No sheath is apparent
Dx
M. ozzardi can be recovered in both blood and skin biopsies
- The organism is nonperiodic so there is no optimum time for collecting blood
Mansonella perstans
Life cycle similar to that of M. ozzardi
- Only known vector is the Culicoides fly
- Infection rates are high in endemic areas which include parts of Africa as
well as selected areas in the Caribbean, Panama, and northern South America
- Primates may harbor the organism & serve as reservoir hosts
Sx
The worms usually appear singly and damage to affected host tissue is minimal
- The organisms usually settle in areas in and around the eye
- Most infections are asymptomatic but moderate eosinophilia and minor allergic reactions may be present
- Calabar swellings, headache, edema, and lymphatic discomfort may also be associated with infection.
Histo
Microfilaria is small and has no sheath
- Body is filled with nuclei that extend all the way to the tip of the tail in the slightly tapered posterior end
- Anterior end is round and blunt
- Blood is the specimen of choice for recovery of the microfilaria and can be collected at any time as the organism is nonperiodic
Mansonella streptocerca
Seen in both monkeys and humans in the Congo basin
- Microfilaria are found primarily in the skin but also in the blood
- Small midges belonging to the genus Culicoides transmit this filaria
Sx
Pruritic dermatitis, with hypopigmented macules and inguinal adenopathy.
Histo
Microfilaria are unsheathed
- Nuclei extend to the tip of the tail which is characteristically bent in the form of a shepherd's crook
Dirofilaria immitis
The dog heartworm, causes a common zoonotic filarial infection in dogs
- Adult worms reside in the right heart of dogs & microfilaria are found in the blood
- Dogs and humans are infected by infective larvae from a mosquito bite
- In humans, the worms do not reach maturity and no microfilaria can be detected in the blood
Sx
Human symptoms: chest discomfort, fever, hemoptysis, perhaps arterial obstruction in fingers
- Males more commonly infected, usually 40-50 yrs. of age
Dx
Histologic examination of surgical or autopsy sections
- Characteristic coin lesions may contain dead or dying worms
- Few human cases, little is known about transmission to humans



W. bancrofti - genital elephantiasis


Wuchereria bancrofti microfilariae




Brugia malayi microfilariae
Brugia malayi microfilaria c tapered tail and last 2 nuclei seen as bumps (arrows) separated by a gap without nuclei



Loa loa microfilariae





Onchocerca volvulus microfilaria



Onchocercomata


Mansonella ozzardi microfilaria


Mansonella perstans distribution

M. perstans microfilaria



Mansonella streptocerca c shepherd's crook ------------->


Dog heart with Dirofilaria immitis

Malaria
300 m. infected, 1.5 - 2 million deaths/yr., usually in child (<5 yo) pts; presents c fever, anemia, splenomegaly (paroxysmal [lasts 6-12 hours])
- within minutes of entering body, sporozoites invade liver cells by attaching to protein receptors thrombospondin and properdin
- merozoites bust out of liver cells and bind to sialic acid residues on glycophorin molecule on RBC surface using a lectin-like molecule
- RBC lysis releases merozoites and causes sx
-- called "blackwater fever" 2/2 hemosierinuria and hemoglobinuria
- Most important parasitic disease of man
Falciparum and Malariae, which do NOT recur in liver are found worldwide; Vivax and Ovale, which DO recur in liver, split the world (Ovale in W Africa, Vivax everywhere else)
Life cycle/history involves over two dozen morphologic forms!!!
- Six stages in the development of the parasite will allow comparison of important species infecting man
(1) Ring forms
(2) developing trophozoites
(3) immatures schizonts
(4) mature schizonts
(5) microgametocytes
(6) macrogametocytes
(1) Ring forms (Early Trophozoites)
Typically a blue cytoplasmic circle connected with a red chromatin dot (Giemsa stain)
- Space inside ring is referred to as a vacuole
(2) Developing trophozoites
Appearance varies with species, numerous growing stages within this category
- Remnants of ring form (cytoplasmic circle & chromatin dot) are present
- Pigment is often visible (primarily brown), and is made of excess protein, iron porphyrin, and hematin left over from the metabolism of hemoglobin by the malarial parasite in the RBC
- Takes up more space within the RBC than the Ring forms
(3) Immature schizonts
Unorganized, evidence of active chromatin replication
- Pigment granules commonly seen
- Occupies more space within the RBC as it grows
- Visible cytoplasmic material surrounding growing chromatin
(4) Mature schizonts
Characterized by emergence of merozoites
- Number and arrangement of merozoites varies according to species
- Cytoplasmic material generally not visible
(5) Microgametocytes
Normally round in shape
- Large diffuse chromatin mass staining pink to purple, surrounded by a colorless to pale halo
- Pigment usually visible, distribution & color vary as to species
(6) Macrogametocytes
Round to oval shaped in most species
- Compact chromatin mass surrounded by cytoplasmic material
- Pigment is present
Thoughts on the Life Cycle
Schizogony
Occurs in the vertebrate host (man)
Introduction of Plasmodium into the host
- Infected Anopheles mosquito bites human & injects
sporozoites (infective stage)
- Sporozoites are transported via blood to the liver where they attach to and enter hepatocytes
Preerythrocytic Cycle
(primary exoerythrocytic schizogony)
- Sporozoites transform into trophozoite within liver cells
- At maturation, trophozoite transforms into schizont
- Schizont undergoes asexual multiplication (schizogony)
- After cytokinesis occurs, resulting organisms are known as merozoites
Erythrocytic Cycle
- Merozoites leave liver cells, attach to and penetrate RBC’s
- Merozoite transforms into a trophozoite (early ring form)
- Trophozoite develops into a schizont which undergoes schizogony, forming merozoites
- Merozoites break out of the RBC’s and infect new erythrocytes
Gametogony
- Occurs after numerous erythrocytic cycles
- Some merozoites entering RBC’s transform into macrogametocytes (immature female gametes)
- Others transform into microgametocytes (immature male gametes)
Sporogeny
- Occurs in the invertebrate host (Anopheles mosquito)
1. RBC’s infected with micro & macrogametocytes enter mosquito gut when female takes a blood meal
- Microgametocytes exflagellate to produce 6-8 flagellated microgametes (male gametes)
- Macrogametocytes mature into macrogametes (female gametes)
- Microgamete penetrates a macrogamete and fertilizes it
- The resulting zygote elongates and transforms into an Oökinete
2. Process of Sporogeny
- Oökinete penetrates gut of mosquito & transforms into an Oöocyst surrounded by a capsule
- Meiosis occurs and sporoblast is formed
- Sporoblast divides asexually to form sporozoites
- Sporozoites are released and migrate to the salivary gland of the mosquito (and are the infective stage for humans)
Plasmodium species that Affect Humans
Plasmodium vivax
Plasmodium malariae (quartan fever)
Plasmodium ovale
Plasmodium falciparum (aka malignant tertian fever)
- Plasmodium knowlesi
- Tertian fever (fever every 48 hours) in P ovale, vivax and falciparum (***in the 3 strains not named malaria...***); Quartan fever (every 72 hrs) in P malaria
- Only P vivax and P ovale can have relapse, though all can have recrudescence (*** P and O in the word hyPnOzoites, f and m are not***)
-- also, P vivax and ovale very similar to each other morphologically, and both can have Schuffner stippling and cause RBC enlargement
Plasmodium vivax
All morphologic forms may also contain Schüffners graniules (fine round red or reddish-yellow dots/granules)
- not seen in W Africa
- Only young RBC's are infected
- RBC's appear enlarged and distorted
Morphological Forms
- Ring forms about 1/3 of the diameter of the RBC
- Single chromatin dot connecting a delicate ring
- May present as a crescent-shaped mass at the outer edge of the RBC (accolé or appliqué)
- Trophozoites have irregular ameboid appearance
- Single large chromatin dot, ring remnants common
- Brown pigment common in trophozoites
- Schizonts have multiple chromatin bodies, clumps of brown pigment
- Chromatin bodies develop into 12-24 merozoites (16 avg.)
- Macrogametocytes have a large pink to purple chromatin mass surrounded by a pale to colorless halo
- Microgametocytes are round to oval with an eccentric chromatin mass & a delicate brown pigment throughout the cell
- P. vivax tends to invade young RBC's
- Duffy blood group negative pts are protected against P vivax (bc Duffy helps in the attachment process)
- The young pliable infected cells increase in size and become distorted
Other thoughts on this Disease
- P. vivax is the most widely distributed malarial parasite
- Disease is referred to as Tertian Malaria or Benign Tertian Malaria
- Symptoms follow a 10-17 day incubation period
- Symptoms: nausea, vomiting, headache, muscle pain, photophobia
- As infected RBC's rupture, the resting merozoites,
hemoglobin, and toxic cellular debris initiate the first series of paroxysms
- Paroxysms typically occur every 48 hrs.
- Chronic infections may result in serious damage to the brain, liver, and kidney
- Dormant hypnozoites may cause relapses months to years later
Plasmodium ovale
MC in tropical Africa, but seen elsewhere
- Only young and immature RBC's are infected
- They appear oval in shape, enlarged, and often distorted with ragged irregular (fringed) cell walls
Morphologic Forms
- Ring forms similar to those of P. vivax but P.ovale ring forms are larger and the ring is thicker
- Trophozoites tend not to be as ameboid as in P. vivax
- Schizonts often maintain a circular shape and the parasite eventually occupies 75% of the RBC
● Mature Schizont is characterized by rosettes of
merozoites (8 avg.)
Some thoughts on the Life Cycle of Pl ovale
- RBC's infected with P. ovale tend to enlarge and assume an oval shape
- Distortion is enhanced by development of a ragged cell wall
Disease Notes
- Ovale Malaria or Benign Tertian Malaria
- Tropical Africa, Asia, S. America
- Clinical scenario resembles that of P. vivax
- 48 hr. paroxysm cycle
- Relapses caused by reactivation of hypnozoites
- Untreated patients typically experience infections for about one yr. (several yrs. for P. vivax)
- Relapses occur years later due to secondary exoerythrocytic cycles (hypnozoites in liver)
Plamodium malariae
Erythrocytic life cycles
- Infects only mature RBC's
- RBC's are normal size without distortion
Morphologic Forms
- Unlike P. vivax and P. ovale, P. malariae does NOT contain Schüffners dots
- Cytoplasm of heavily stained P. malariae may contain Ziemann's dots
- Ring form typically occupies about 1/6 of RBC diameter
- Trophozoites → non-ameboid solid cytoplasm that may assume a banded, bar, or oval or round shape
- Mature schizonts typically contain 6-12 merozoites arranged in rosettes or irregular clusters
Some thoughts on Pl. malariae
- Quartan Malaria or Malarial Malaria
- found in Subtropic & Temperate regions
- 18-40 day incubation period followed by flu-like
Symptoms
- Cyclic paroxysms occur every 72 hrs.
- Spontaneous recovery may result after initial infection
- No true relapses as dormant hypnozoites are not
associated with P. malariae
- May cause a recrudescence or a series of recrudescences due to low-grade parasitemia
- Repeated attacks may occur for 20 yrs. or more
Plasmodium falciparum
Most deadly spp (resistant to chloroquine); sticks to capillary endothelium, causing vascular probs in kidney, lungs and brain
- P. falciparum infects RBC's of all ages
- Infected cells are of normal size without distortion
- No Schüffner's dots or Ziemann's dots
- May contain Mauer's dots
Morphology
- Small delicate ring forms consisting of scanty cytoplasm connected to one or two shall chromatin dots (circle configuration or headphone configuration)
- Multiple rings in an infected RBC are frequently seen
- P. falciparum can produce accolé or appliqué forms
- Trophozoites characterized by "heavy" ring forms
- a high percentage of infected RBC's are seen
- Mature trophozoites not routinely seen in peripheral blood
- Schizonts as well are rarely seen in peripheral blood
- Mature schizont has 8-32 merozoites (24 avg.) in a cluster arrangement and are seen only in very severe infections
- Gametocytes have diagnostic banana/crescent shaped (***in Malaria, Bananas are Bad!***)
Development of all growth stages after ring forms occur in the capillaries of the viscera
- causes RBCs to stick together (Rosette) and stick to endothelial cells (sequestration) on receptors (CD36, thrombospondin, VCAM, ICAM) using P falciparum erythrocytes membrane protein 1 (PfEMP1) causing ischemia (major cause of mortality in children)
- Only young ring forms and gametocytes are seen in peripheral blood
- Hypnozoites are not produced in the liver and true relapses do not occur
- Presence of schizonts in peripheral blood indicates a very grave prognosis
- Recrudescence may occur and such attacks may be fatal
- Malignant Tertian Malaria
- Short incubation period of 7-10 days
- Daily episodes of chills & fever rapidly develop
- These are followed by cyclic paroxysms every 36-48 hrs.
- Severe diarrhea, nausea, vomiting
- A fulminating disease results along with the intestinal symptoms (massive hemolysis)
- P. falciparum produces the most deadly form of malaria and thus must be correctly id'd
- Brain, kidney, and liver may be involved
- Kidney involvement: bloody urine (hematuria), acute renal failure, Blackwater fever, tubular necrosis, nephrotic syndrome, death
● Brain involvement causes blockages from capillary plugs, causing small focal inflam reactions (malarial / Durck granulomata) leading to coma, death
Plasmodium knowlesi
aka Simian Malaria
- Newly emergent and is found primarily in monkeys in peninsular Malaysia
- human infx now recognized in Singapore, Philippines, Thailand, Myanmar, parts of China and Malaysia, but is now considered the fifth human malarial parasite
- distribution confined to Southeast Asia bc mosquitoes of the Anopheles leucosphyrus group are the only ones capable of transmitting the parasite
- Regional differences in disease severity exist
- can cause uncomplicated, complicated or fatal dz
-- prompt and accurate dx and tx is therefore essential
--if detected early enough, infx is readily treatable
Has 24-hour cycles (quotidian) which is unique among primate malarias
- infx in any cell regardless of age (heavy infx can result) including RBCs of any size (though most are of normal size)
Dx
Difficult to distinguish Pl malariae and Pl knowlesi microscopically
- molecular detection methods are the best to distinguish bwt these 2 bugs
- previously most cases were misdiagnosed as Pl malariae due to similarities in RBC stages (esp band forms)
- No Schuffner's dots (faint clumpy dots seen late in the cycle)
- late and mature trophozoites, schizonts and gametocytes generally indistinguishable from those of Pl malariae
Has multiple rings/cell (usually 2-3)
- delicate rings (2-3 chromatin dots per ring, applique forms)
- early trophozoites similar to those of Pl falciparum
- Pl malariae does not ever cause severe infx
- Pl knowlesi multiplies daily resulting in high parasitemia that can cause death
- band form trophozoites are commonly seen
- mature schizont has 16 merozoites, no rosettes (6-12 for Pl malariae)
- Gametocytes are round and tend to fill the cell
Control and treatment of malaria
Vector control
Vector: female Anopheles mosquito
- Breed in water, each species having it's preferred breeding grounds, feeding patterns, resting places
- Control measures include insecticides, draining swamps, oil sprays, etc.
- Insecticide resistant strains of mosquito have developed
- DDT most effective but banned in many areas
- Biological control: mosquito eating fish
- Mosquito nets, etc.
Treatment
- Quinine: derived from Cinchona bark
- Chloroquine: synthetic antimalarials
- Primaquine → used to kill the liver-phase organisms (hypnozoites)
- Chloroquine-resistant strains of P. falciparum are widespread
- Work continues on antimalarial vaccines
Artemesinin-based Combo therapies
- Artemisinin used c a partner drug, bc cannot be used as an oral monotherapy
- artemisinin rapidly diminishes the main parasite load during the first 3 days of tx but cannot destroy all the parasites (need the partner drug for a cure)
- ACTs recommends as the first-line t for uncomplicated Pl falciparum infx
-- although insome places Pl falciparum has become resistant to all available meds (including artemisinin)
Babesiosis
Babesiosis is a zoonosis, with extraerythrocytic ring forms, but no pigment, schizonts or gametocytes seen
- Cause of Red Water Fever in cattle, causes nonperiodic fever, anemia, leukopenia and abnormal LFTs in humans
- About 90 human cases have been described
- As of January 2011, Babesiosis in the U.S. is a nationally notifiable disease
Vector is the Ixodes tick
- Reservoir for B microti is white-footed mouse
- Etiologic agent in the U.S. is primarily Babesia microti (which may be reclassified as Theileria microti based on ribosomal RNA studies)
- Babesia divergens may also cause human infections
- In U.S; N.E. coastal region, Georgia, Wisconsin, Minnesota, six cases from the West Coast
- may be acquired by transfusion, since survives well in the fridge
Sx
General malaise, fever, chills, arthralgias, myalgias, dark
urine, headache, rapid hemolytic anemia
- Patients with previous splenectomies have most severe disease (often fatal)
Dx
Thick and thin blood smears as for Malaria
- Only the trophozoite stage is present in human RBC's
Histo
Ring forms are "pyriform" (pear-shaped), round, oval, elongated, or ameboid
- Ring forms resemble those of P. falciparum but are smaller (organisms are only 1-2μm)
- They have a tiny chromatin dot & a minute amount of cytoplasm
-- 1 or 2 chromatin dots are often seen without noticeable cytoplasm
As they mature, they appear as pairs or tetrads in the RBC
- Tetrads are known as the "Maltese Cross" formation (diagnostic)
- Erythrocytes are of normal size and shape
How does babesia compare to plasmodium falciparum??
It is believed that several cases of babesiosis have been diagnosed as P.falciparum.
- RBC's are normal size and shape with Babesia infection.
-- They are not enlarged or pale as in some species of Plasmodium.
No malarial pigment deposits seen and no stippling
in the RBC's as in the older forms of malaria.
- Babesia do not resemble the older forms of P.falciparum to the degree that they resemble the younger forms; reviewing several sets of slides over a period of days is helpful.
Parasitemia of Babesia persists after chloroquine and other antimalarials are given.
- Babesia patients have intermittent fever, but there doesn't seem to be the pattern that so often accompanies the malarias.
- The clinical and social history of the patient is an absolute necessity
Balantidium coli
Think this bug when you see an organism with cilia uniformly surrounding the surface
- has a kidney-shaped nucleolus
- cyst form has cilia that are visible beneath outer cyst wall (cyst also has kidney-shaped nucleus


Trophozoites in thin smear (left) and thick smear (right)

Schizonts









P. vivax- Ringed-stage trophozoites
Increasingly mature trophozoites
P vivax ameboid ring form

Schuffner's dots

P vivax - Increasingly mature schizonts (#19-27)


Plasmodium vivax - mature schizonts (above and below)

28 and 29: Mature macrogametocytes
30: Microgametocytes (male)

P ovale ring stage parasites
P ovale ring forms
P ovale trophozoites

Plasmodium ovale trophozoites
Plasmodium ovale - schizonts
Plasmodium ovale gametocytes

Pl. ovale - gametocytes

Plasmodium malariae ring forms

Plasmodium malariae developing trophozoites

Pl malariae developing trophozoites (band forms)

Pl malariae increasingly mature schizonts
Pl. malariae schizonts


Pl. falciparum ring-stage parasites

Pl falciparum ring forms

Pl falciparum gametocytes









Maltese cross and ring forms of Babesia
Phylum: Apicomplexa
Class: Sporozoa
Genera: Cystoiospora, Isospora, Sarcocystis, Cryptosporidium, Cyclospora
- Members of this phylum, previously referred to as Sporozoa, are generally tissue parasites
● Apicomplexa have a complex life cycle with alternating sexual (sporogenic) and asexual (schizogonic) generations.
Blood Parasites: Plasmodium spp.
GI tract parasites: Isospora, Cryptosporidium, Sarcocystis, Cyclospora
Organ/tissue parasites: Toxoplasma, Sarcocystis
General life cycle
- All genera have a life cycle that includes:
1. Definitive host : Sporogony (sexual cycle)
- Gametocytes (macro - micro), Zygotes, Oöcyte, Oöcysts, Sporozoites
2. Intermediate host: Schizogony (asexual cycle)
- Merozoites, Trophozoites, Schizonts, Gametocytes
Cryptosporidium parvum
Coccidian parasite (2nd MCC intestinal parasite)found worldwide in birds, reptiles, fish and mammals
- at least 30 spp (lots of subtypes per molecular, all unable to be distinguished from traditional lab tests), but only a few cause dz in humanos
- C. parvum and C. hominis in humans
First cases reported in 1976 in immunodeficient (c fluid loss ie AIDS pts)
Due to infected water sources!!! (Swimming pools!)
- usually in kiddos (DAYCARE)
- may cause biliary tree strictures
Sx
acute diarrhea (in 100% of cases, usually a self-limiting)
Dx
Diagnostic stage = Oöcyst
Infective stage = Oöcyst
Specimen of choice = Stool or Duodenal Biopsy
- dome-shaped basophilic thingies adherent to brush border on duodenal bx (actually intracellular)
- weakly acid-fast oval eggs in stool sample
IHC
Stool (sometimes confused with yeast)
Acid fast stains (Oöcysts), Iodine (Oöcysts)
Direct detection: FA, ELISA (Oöysts, Antigen)
Duodenal Biopsy
- Routine histological stain (H&E stain)
- Enterotest
- Electron microscopy (EM)
- Oöcysts and other developmental stages(gametocytes, schizonts, etc.)
Sx
- Nausea, low grade fever, abdominal cramps, diarrhea (usually self limiting [lasts 2 weeks])
-- In immunodeficient patients, severe and prolonged diarrhea (fluid loss becomes significant may lead to death.
Tx
Nitazoxanide and anti-diarrheals
- IV fluids for severe volume and electrolyte loss
Isospora belli (Cystoisospora)
Similar to Cryptosporidium in that it also causes a self-limiting diarrhea (worse in immunocompromised hosts)
I. belli is infects humans only
- unknown life cycle (no intermediate host)
Schizogony and sporogony in GI tract
- Schizogony: asexual stages - infection spreads within the GI tract
● Sporogony: sexual stages - formation of oöcysts
● Oöcysts are passed in stools → serves to spread the infection to new hosts via ingestion of faecally contaminated food and water.
● In the intestine the freed sporozoites enter the epithelial cells life cycle begins
Dx
Oöcysts (various stages of development)
Infective stage = mature oöcysts ingested
Gold standard = Poo or GI bx
Poo = DWM - Sheathers sugar flotation technique, Oöcysts (reduce illumination to observe, float under coverslip), acid fast stains and iodine = Oöcysts
- PVA not recommended bc distorts morphology
GI bx do H&E (developmental stages within the mucosal cells); weakly acid-fast elliptical eggs between enterocytes with 1 (unsporulated) or 2 (sporulated) sprocysts
Sx
- diarrhea (worse in immunocompromised), weight loss, fever, self-limiting
Tx
trimethroprim-sulfamethoxazole (TMP-SMX) or pyrimethamine / sulfadiazine
Cyclospora (cayetanensis)
Intestinal coccidial organism whos life cycle is not well understood (only seen during certain months)
- Not detected c standard processing (molecular?)
- children in Peru, travelers in Asia most likely 2/2 contaminated water (like crypto)
Dx
- Diagnostic stage = Oöcysts (with 2 sporocysts that each have 2 sporozoites)
- Infective stage = mature Oöcysts (ingested- thus best to check stool)
- modified acid-fast (Kinyoun) organism bx or stool
- no assoc c immunocompromised
Histo
- Wet mount = nonrefractile spheres
- Modified Acid Fast (Kinyoun)= variable results , oocysts light pink to deep red with "bubbly" granules
- trichrome = Oöcysts clear, round, wrinkled if observed
- Size: Oöcysts 8-10 μm
Sx
Malaise, low-grade fever, prolonged diarrhea
- explosive diarrhea 1 to 3 weeks
- Weight loss, flu-like illness, nausea, vomiting
Tx
TMP-SMX
Sarcocystis
accidental or intermediate host in humans found in intestine and muscle (where they make long tubular masses [Mieschers tubules]) usually asymptomatic (even in immunocompromised)
- Sporozoites are located in the spores.
- unknown life cycle; hour-glass eggs c 2 sporocysts
-- transmitted by eating flesh with Mieschers tubules or oöcysts in faecally contaminated food
- rarely infects man (low virulence)
Dx
Diagnostic stage = Oöcysts (sporocysts each c 4 sporozoites)
Infective stage = oöcysts (ingestion)
Specimen of choice: Poo or GI/Muscle bx
- Poo - FA or Iodine (oöcysts)
- GI/Muscle Bx: Mieschers’ tubules
Blastocystis hominis
Originally thought to be a nonpathogenic yeast or algae, some experts still think has protozoan links (2/2 pseudopod extension & retraction)
- molecular studies found not fungal or protozoan
- fecal-oral transmission
- found in asymptomatic normal and immunocompromised pts (may not even be a pathogen)
Histo
Best seen c trichrome, classic round form c membrane-bound central (fluid-filled) body that takes up to 90% of the cell, 2-4 nuclei in cytoplasm
Specimen of choice: stool
- Wet preparations not reliable
Tx
Metronidazole (Flagyl) or diiodohydrozyquin (Yodoxin)





C. parvum with 4 sporozoites



Isospora (Cystoisospora) belli oocysts

Sporulation of Cyclospora Oocysts
Trichrome and safranin stains




Oocysts c 2 sporocysts when is mature, each c 2 sporozoites

Sarcocystis - thin-walled oocysts and sporozoites; indicidual sporocysts each c 4 sporozoites (right 2 pics)



Blastocystis hominis cyst forms





Microsporidia
Fungus (was a protozoan...), obligate intercellular parasites, that includes 170 genera, 1300 species (11 in humans); have 70s ribosomes (like bacteria) and smallest genome of any eukaryote
- in man: Encephalitozoon, Trachipleistophora, Nosema, Brachiola, Vittaforma, Enterocytozoon
-- 3 of the 5 genera in AIDS pts (up to 1/3 AIDS pts infected in USA)
- microsporidia with diagnostic spores by no developing stage are collectively called Microsporidium
-- Double infections with Cryptosporidia and Microsporidia are common
MC organism Enterocytozoon bieneusi causes chronic diarrhea from malabsorption
- Encephalitozoon and Trachipleistophora (Pleistophora) cause severe tissue infections in AIDS patients.
- Microsporidium or Nosema = corneal infections (keratoconjunctivitis)
- can also get myositis
- Intestinal infection (diarrhea, wasting dz, malabsorption, gallbladder dz); pulmonary infx (cough, difficult labored breathing); cavitary lesions on CXR)
- cystitis / UTI leading to renal failure, perforation of the bowels
Transmission may be direct or it may involve an intermediate host.
- Human infection is initiated when the infective spores inject sporoplasm into a host cell
- A complex reproductive process occurs, new spores emerge, and new cells become infected.
- Spores are dispersed into the outside environment in the direct transmission cycle in the feces, urine, or by the death of the host
- spores may also be ingested by a carnivorous animal eating imeat that has been infected
Histo
Lots of small spores in apical region of enterocytes that have extruding polar filaments (tubules) that injecting sporoplasm (infectious material) into a host cell (need EM to dx)
Dx
Standard techniques ineffective, must use IFA procedure or acid-fast and periodic acid- Schiff (PAS) stains or electron microscopy.
- Very thin acid-fast or Weber's trichrome-stained fecal smears may reveal intracellular spores
- Serologic tests are available for some species and some species will grow in cell culture.
- Chromotrope 2R and Hot Gram Chromotrope technique c light microscopy
- Speciation of the Microsporidia requires transmission electron microscopy
- PCR molecular probes, cell culture can also be used
Tx
None
- fumagillin may help against intersinal microsporidiosis (Aspergillus fumigatus), Nosema apis and Nosema ceranae from honey bees
- possibly albendazole also
Toxoplasma gondii
Obligate intracellular parasites (OIP) found worldwide
- schizogony and sporogeny in host's epithelial cells in small intestine
- 70% serologic positivity in US (can acquire from ingestion of oocysts in cat feces, raw meat [MCC, 50%], milk, or transplacentally)
- definitive host = cats
- oocysts found in feces
Sx
Most infections are benign - asymptomatic
- fetal loss if primary infx in early gestation fetus and fetal CNS infx (chorioretinitis [blindness], encephalitis, retaration) if primary infx in late pregnancy (will not happen if mother has already had infx)
- Organ transplants - infection in the recipient from donor infected organ (cysts located in tissue).
- problematic in compromised hosts when become encysted in tissue when the person is healthy and remains encysted for many years only to become reactivated when the immune defense becomes weak
Cerebral toxoplasmosis MC form in AIDS patients, can also infect spinal cord, lung and heart
- seen as a ring-enhancing abscess
2 trophozoite forms in humans:
1. Tachyzoites
- Extracellular crescent-shaped, actively proliferating trophozoites, seen in early, more acute infections (tachy = rapid)
- Rupture from the cell and infect new cells
- Spread infection -- causing tissue damage
2. Bradyzoites
Resting form trophozoites found in cysts (histiocytes packed c tachyzoites??) (brady=slow) in chronic infx of muscle and brain
- in check by host's immune system c antibody, gamma IFN, T-cell factors
Dx
Abs or biopsy (diagnosis is seldom made by recovery of the organisms)
- Infective stage: Oöcysts
Gold standard specimen = Serum (for IFA, ELISA, IHA or Sabin-Feldman dye test [confirmatory])
Sabin-Feldman dye test. T. gondii tachyzoites in the presence of immune serum, lose their affinity for methylene blue stain. HAZARD: Live organisms needed!
-- if IgM low positive in serum, may be new infx or infx in last 2 yrs, need to draw again in 2 weeks
- Biopsy can be used for staining cysts
- Body fluids use serological tests (confirmatory if ab level is higher in CSF than in serum)
- Direct isolation, tissue culture, animal isolation may also be used
- Presence of tachyzoites is confirmatory
Tx
Combo of pyrimethamine and trisulfapyrimidine in acute infections
- Indoor/outdoor cats - change litter box daily
- Pregnant and serologic negative → CAUTION
-- must cook meat properly
Myxozoa
Primarily a parasite of fish, their spores are made of chitin and can pass through the human GI tract, and can cause GI sx in anyone (but esp HIV pts), including those of Henneguya salminicola and Myxobolus plectroplites
- spores of Henneguya salminicola look like sperms
Nematodes
Mostly free-living, many are plant parasites, some are animal parasites, about a dozen are found in man.
- 1/2 million described species
- grossly similar to earthworm
- Phylum Aschelminthes, class Nematoda
- Non-segmented, generally cylindrical, tapered at both ends, covered with a tough protective covering or cuticle, complete digestive tract
- Sexes are separate with males being smaller than females
Ascaris lumbricoides (Large Intestinal Roundworm)
MCC intestinal helminth affecting 1/4 humans worldwide (2nd MC in US after pinworm); ~50 spp
Acquired by ingesting eggs containing larvae which hatch in duodenum; larvae penetrate intestinal mucosa and enter blood, where carried to lung
- after entering the alveoli, larvae molt twice and develop into fourth stage larvae which migrate to pharynx where swallowed and pass through the stomach and into the small intestine (again)
-- final molt to adults occurs in small intestine where female worms begin to release eggs
May be contracted in raw foods fertilized c night soil
- ~50% of eggs remain infective for up to 10 years
Sx
Normally a b9 disease with low morbidity & mortality
- 20k deaths per annum 2/2 intestinal obstruction
- can present as either Larval migrans or as Adult worms
Larval Migrans
- larvae cause small hemorrhages in the alveoli
- Cellular & serous exudates accumulates in alveolar spaces causing fever, asthmatic breathing, frequent coughing, and bronchial rales
- Loefflers syndrome: pronounced pneumonia-like syndrome with production of lots of yellowish sputum
Adult Worms
- Adult worms feed on liquid contents in the small intestine
- see colicky epigastric pain & vague abdominal discomfort
- Intestinal obstruction due to large worm burden in ileum
-- Abnormal migration of adult worms produce varied and sometimes serious consequences
- Adult worms can be vomited or come out the mouth, nose, or anus
Dx
Eggs in the feces
- Fertilized eggs are unembryonated, and have a thick, bile stained shell covered with many small round projections called mammillations (corticated)
- Infertile eggs may be elongate or bizarrely shaped and distorted
-- If concentration techniques are used, sedimentation (using formalin-ether) better than floatation procedures
May also dx if adult worms recovered
- Male worms measure 15-31cm, females 20-35cm
DDx: earthworm (an annelid [not ascarid] with blood vessels seen on low power and segmentations)
Tx
Albendazole or mebendazole
- can be controlled by not using human feces as fertilized and proper hygiene
Enterobius vermicularis (Pinworm)
MCC helminth infx in USA
- acquired by ingesting eggs (usually direct hand to mouth) c third-stage larvae that hatch in small intestine and liberated larvae migrate to the
ileocecal area to develop into adult worms
- Adults attach to mucosa where they feed on bacteria and epithelial cells
- When gravid, females migrate through the intestines to the anus; then at night, the females migrate out of the anus, deposit their sticky
eggs on the perianal skin, and die
- Retroifection can also occur when eggs hatch and larvae migrate back into the anus and mature into adult worms in the intestine
Sx
1/3 of all cases asymptomatic
- Symptoms are minimal in other cases with nocturnal perianal itchiness associated with migration of gravid female worms
-- Intense itching may provoke scratching resulting in hemorrhage, eczema, and secondary bacterial infection
- Irritability, insomnia, nervousness, inattention, etc.
- can migrate into the genital tract of young girls and possibly lead to vulvovaginitis, pelvic inflammatory disease, and granulomas of fallopian tubes or peritoneal cavity
Dx
Finding eggs in perianal region using scotch
tape or commercially available "Pinworm Paddles"
- sample collected at night or immediately after the
child awakens in the morning (6 consecutive mornings)
- Eggs usually embryonated, 50-60μm long and 20-32μm wide, flat on one side and have a translucent shell
- Adult worms are occasionally seen (light yellowish white color with cephalic alae at the anterior end)
Trichuris trichura (Whipworm)
Humans infected by ingesting eggs containing first stage larvae; 1/2 million (mostly kids) infx worldwide (usually in places c poor sanitation) and can coexist c Ascaris
- Eggs hatch in the duodenum where the larvae grow and develop, then the larvae then migrate to the cecum & develop into adults
Adults have a long slender esophageal region that constitutes about 2/3 of the body length and a thickened posterior region giving them the whip look
- anterior end gets threaded into the intestinal mucosa
- After fertilization, the females begin producing barrel-shaped eggs that are passed in the feces
Sx
Usually asymptomatic sometimes vague GI sx
- can cause rectal prolapse
- Massive infantile trichuriasis may occur in young children with heavy infection (Other agents may also be involved)
- Trichuris induced anemia is rare
Dx
Find eggs in poo c barrel-shape and clear "polar corks" at each end
- Eggs are unembryonated and a direct fecal smear is usually sufficient for detecting significant infections
Necatur americanus and Ancylostoma duodenale (Hookworm)
~1 million ppl infected in tropical areas c poor sanitation and good soild conditions, usually in young white girls
Two species of hookworm infect humans:
- Ancyclostoma duodenale or Old World Hookworm
- Necator americanus or New World Hookworm
- N americanum has cutting plates, A duodenale has teeth
(***the American must first cut on his plate before chewing with his teeth to put in the duodenum***)
- both have a long buccal cavity and indistinct genital primordium (vs S strongyloides)
3 Major Phases: Cutaneous, pulmonary, and intestinal
Humans infected when third-stage filariform larvae penetrate skin exposed to contaminated soil
(usually on the feet, hands, or butt) - causes localized dermatitis, called the "Ground Itch"
- if ingested, filariform larvae can penetrate oral mucosa and complete development to adults w/o lung migration
- Larvae normally enter venules and lymphatic vessels and are then carried to the heart
- they then go to the capillary beds of the lungs, to the alveoli, and migrate up the respiratory tract to the pharynx - cause fever, headache, nausea, dyspnea, pharyngitis (Pulmonary phase)
- then swallowed and pass down the digestive tract to the small intestine
- these fourth-stage larvae attach to villi of the intestinal mucosa where they undergo a final molt to become adults after feeding off blood and tissue, which can cause heart failure, chronic iron deficiency
About 5wks. after initial infection, adults reach sexual maturity, fertilization occurs, and the females begin to release eggs
- If the feces are deposited on favorable soil (shaded, warm, moist) embryonation continues and first-stage rhabditiform larvae hatch in 24-48hrs.
- The rhabditiform larvae molt to second-stage rhabditiform larvae and then to third-stage filariform larvae (infective stage) and wave snake-like in the air
awaiting contact with bare skin of a suitable host
Dx
Eggs in feces (eggs of hookworm and S stercoralis are identical)
- if there is a long delay before fecal specimens are examined, the first-stage larvae may develop and hatch from the eggs
- should distinguish the rhabditiform larvae of
hookworm from the rhabditiform larvae of Strongyloides and Trichostrongylus spp. (which is done by looking at the buccal capsule of the adult worms)



Microsporidium spore

Microsporidium spore c polar tube out




Tgondii unstained cyst


T gondii cysts in the brain


Myxozoa
Myxobolus insignis



Ascaris lumbricoides intestinal obstruction

Ascaris lumbricoides


Ascaris lumbricoides: (lt) fertilized egg; (middle) un- and fertilized eggs; (rt) 3 fertilized eggs, one decorticated





Pinworm eggs on scotch tape test


Pinworms around anus


Rectal prolapse

T. trichura c barrel-shaped eggs c clear polar plugs at each end
Trichuris trichura (whipworm) adult

Hookworm - cutaneous phase

Hookworm eggs

Rhabditiform (lt) and filariform larva (rt)
Strongyloides stercoralis (Threadworm)
A cosmopolitan parasite, but generally not as
prevalent as other major nematode infections
- MC in tropical & subtropical climates
- 85% of population may be infected in rainy areas
- In the U.S. it is endemic in rural South Eastern states and Appalachia
- has both a parasitic and a free-living stage
There are three basic life cycles, which determines the clinical sx
1. Direct Life Cycle
- Similar to the life cycle of hookworm
- Filariform larvae penetrate skin from the soil, go to the lungs and become juvenile adults
- Young adults migrate up the respiratory tree, are swallowed and complete their development in the small intestine
- The only sexually mature stages in the intestine are females
- First-stage rhabditiform larvae hatch from the eggs while still in the mucosa, burrow into the intestine, and are carried out in the feces
- Depending on environmental conditions, the larvae may complete a direct type life cycle or may initiate a free-living stage
2. Indirect Life Cycle
- essentially a free-living cycle that occurs in tropical
climates
● The rhabditiform larvae passed in the feces develop into free living males and females in the soil
● Once fertilized, the females release partially embryonated eggs which complete their development to rhabditiform larvae which develop into more male & female adult worms or into infective filariform larvae (all occurs in the soil)
3. Autoinfective Life Cycle
- Autoinfection occurs when first-stage rhabditiform larvae in the intestine prematurely molt into filariform larvae that immediately reinfect the host
- If this occurs while still in the intestine, it is termed
internal autoinfection, but if reinfection occurs when larvae penetrate perianal skin soiled with feces, it is termed external autoinfection
-- either way the larvae undergo the same circulatory-pulmonary-gastrointestinal migration as in the direct cycle
- Autoinfection results in the number of adults increasing in the absence of reexposure
- Hyperinfection occurs when internally autoinfective filariform larvae are uncontrolled and massive, frequently fatal, dissemination of larvae to numerous distant organs ensues.
Sx
Cutaneous phase
Asymptomatic or can have small papules or macules at the site of penetration
- If large numbers of larvae are involved there may be a prominent pruritic erythema
- If hypersensitivity is a factor, the manifestations are even more severe (rash petechiae, edema, inflammation)
- Larval currens: in chronically infected individuals there may be snake-like tracts in the skin that resemble cutaneous larval migrans
Pulmonary phase
Variable, but include pneumonitis or bronchopneumonia accompanied by a prominent eosinophilia
- Shortness of breath, coughing up blood, throat irritation, and a mild cough
Intestinal phase
- Also highly variable, may be asymptomatic or mild
- Immunocompromised patients may have symptoms that are particularly severe and may even be fatal
- Severe enteritis or intestinal perforation can occur
Dx
About 50% of cases are confirmed by finding characteristic larvae in feces if multiple specimens are examined using appropriate concentration techniques
- Definitive examination of the stool requires culturing in a Baermann apparatus
- Should be able to differentiate Strongyloides spp. from hookworm or free-living nematodes (very similar and also found in feces)
- The Entero-Test can be used to sample duodenal contents and may reveal the larval stage
Tx
Albendazole and Ivermectin
Trichinella spiralis
Causes trichinosis, a parasite of carnivores with very little evidence of host specificity
- Infection in humans results from ingestion of insufficiently cooked pork or pork products containing encysted larvae (bear meat is also a frequent source of human infection)
-- adult worms live in the small intestinal mucosa and produces and discharges larvae which enter the bloodstream and invade the skeletal muscle
- The larvae undergo further development and encapsulation in the muscle tissue in nurse cells
-- encysted larva remain viable for many years
Sx
Initially nonspecific gastroenteritis, fever, eosinophilia, myositis, and circumorbital edema
- Adults survive in the intestine for 6-8 wks. and are then expelled
- body forms a TH2 cellular response against this and other invasive nematodes
Dx
Find encapsulated larva in biopsy specimens from skeletal muscle (esp the deltoid and gastrocnemius muscles) usually c some surrounding eos
- Digestion of muscle tissue in artificial gastric juice followed by examination of the sediment for larvae is more sensitive
-- Serological tests are widely used with good results bc highly antigenic and stimulates a strong Ab response
- MC tests are bentonite flocculation, complement fixation, and IFA (stimulates strong Ab response)
- Measurable Ab does not appear until 3-4 wks. postinfection so that negative sera during acute attack should be confirmed by taking a convalescent sample
● Specificity is excellent, titers persist for years
Dracunculus medinensis ("guinea worm")
In Africa, the Middle East, India & Pakistan
Adult worms live in the subcutaneous tissues and infection becomes evident when female worm migrates to the body surface, making a blister on the foot or ankles that ruptures on contact with water
- Upon rupture of the blister, the female worm discharges swarms of motile larva into the water (only a small portion of the worm is extruded
from the lesion but it can be removed by gentle traction)
- Secondary bacterial infections of the lesions are common & may be temporarily disabling
The life cycle involves transmission via a biologic vector, a copepod, which ingests the first-stage larvae liberated by the female worm
- After development of the larva to infectivity, ingestion of infected copepods by humans (in drinking water) can result in transmission of infection
Dx
Appearance of the female adult worm on the
surface of the skin
Tx
The administration of various drugs helps to relieve symptoms and may facilitate removal of the worms.
- Controlled by drinking clean water (without infected copepods)
Larva Migrans
Several species of nematode parasites which are animal hookworms and undergo partial development
- The severity of subsequent disease manifestations may vary from asymptomatic to serious in the form of skin rash, pneumonitis, and CNS involvement
1. Cutaneous Larva Migrans:
aka "creeping eruption" or "ground itch", refers to production of serpiginous , inflamed trails in skin
- 2/2 skin contact with sandy-loam soils that
contain filariform larva of hookworms discharged in the feces of dogs & cats and other animals
- In the Southeastern U.S. this may be an occupational hazard of electricians, plumbers, and construction workers when working under houses where animals have defecated
Ancyclostoma braziliense, a hookworm of dogs & cats, has been the species usually identified with classical creeping eruption acquired along sandy beaches
- These larva may also invade other tissues and organs including the eye, where they produce granulomatous, visceral-larva-migrans-like lesions
Dx
Find classical serpiginous trails
2. Visceral Larva Migrans:
A syndrome originally associated with the larval migration in humans, especially 3 dz's assoc cchildren, of dog & cat ascarids of the genus Toxocara
- Many species of animal helminths may infect humans and migrate through organs and deeper tissues of the body
ie Toxocara canis , the dog ascarid
Toxocariasis results from the ingestion of infective eggs from soil and is characterized by hypereosinophilia, hepatomegaly, fever, pneumonitis, and occasionally death (pica in kiddos)
- may persist for many years and may result in severe complications involving the eye and the CNS
-- other nematode larva producing visceral larva migrans include Ancyclostoma caninum , and Gnathostoma spinigerum
Dx
Difficult, generally based on clinical findings
and immunodiagnostic procedures.
- Occasionally diagnosis is established by finding focal inflammatory lesions containing larva in tissue specimens (liver, brain, other organs)
Capillariasis
Capillaria philippinensis (found in Philippines and Thailand) causes human intestinal capillariasis
- Two other Capillaria spp. parasitize animals with rare human infection
- C. hepatica causes human hepatic capillariasis and C. aerophila causes human pulmonary capillariasis
Capillaria philippinensis: typically, unembryonated eggs are passed in the human stool
- After ingestion by freshwater fish, larva hatch, penetrate the intestine and migrate to the tissues
- Eating raw or undercooked fish results in infection of the human host
- Adult worms live in the small intestine where they burrow in the mucosa
- Adult females deposit unembryonated eggs some of which become embryonated in the intestine and release larvae that can cause autoinfection. This leads to hyperinfection (massive# of adult worms)
Capillaria philippinensis is currently considered a parasite of fish-eating birds which seem to be the natural definitive host
- C. hepatica and C. aerophila have unique and distinct life cycles that differ from that of C. philippinensis
Sx
Intestinal capillariasis = abdominal pain & diarrhea which may become severe because of autoinfection
Hepatic capillariasis = acute/subacute hepatitis with eosinophilia and possible organ dissemination
Pulmonary capillariasis = fever, cough, asthma, pneumonia
All forms can at times be fatal
Dx
C. philippinensis: unembryonated eggs in stool or in intestinal biopsies. Severe cases: embryonated eggs, larvae, and even adult worms can be seen
C. hepatica: adult worms and/or eggs in liver tissue biopsy or necropsy
- Identification of C. hepatica eggs in stool is a spurious finding resulting from ingestion of livers from infected animals
C. aerophila: find eggs in stool or lung biopsy
Anisakiasis
Increased number of human infections due to popularity of eating raw fish dishes (sushi, sashimi, ceviche, Tahitian Salad, etc.)
- A number of genera including Anisakis and Pseudoterranova are parasites (as adults) of marine mammals, utilizing shrimp-like crustaceans as first intermediate hosts
- They use fish and squid as second intermediate hosts in their life cycle
- Larval stages in the fish have the ability to pass from one fish to another when ingested without maturing to adult worms
Sx
Larva may partially penetrate the wall of the stomach or intestine and produce an eosinophilic granuloma (seen after 1-2 wks, and can mimic Crohns disease)
- Human infections present with acute abdomen or signs of intestinal obstruction
- In some instances, worms may be coughed up or removed from the throat where they may have attached
Dx
Finding whole worms or by examination of the microanatomy of the parasites in histologic section
Tx
Endoscopic removal of worms



S. stercoralis 1st-stage rhabditiform larva c prominent genital primordium on the right

Strongyloides eggs. Careful!!! Very similar to hookworm eggs
Strongyloides hyperinfection

Strongyloides hyperinfection in duodenum


Trichinella spiralis larva freed from their cysts


Encysted larvae in muscle tissue


Extraction of the female worm

Dracontiasis
Cutaneous larval migrans


C. philippinensis eggs, pill-shaped c polar plugs and striated shell

Gastric anisakiasis


Arthropods
All have:
1. jointed appendages in pairs
2. a chitinized exoskeleton
3. a hemocele
4, bilateral symmetry
Sx
- Humans who have been bitten or stung may exhibit symptoms related to the specific encounter with the arthropod
Classification
The phylum arthropoda contains five classes of medically significant arthropods:
Chilopoda (Centipedes)
Pentastomida (Tongueworms)
Arachnida (Ticks, Mites, Spiders, Scorpions)
Crustacea (Crabs, Crayfish, Copepods)
Insecta (Flies, Mosquitoes, Lice, Fleas)
Ticks
Ticks are divided into two major groups, hard ticks & soft ticks
- Both types are round in shape, the head, thorax, and abdomen are meshed together and appear as a single unit
- They have four pairs of legs, no antennae, sexes are separate
Have an anterior capitulum (the mouthparts)
Hard ticks: capitulum is visible on the dorsal side
Soft ticks: capitulum is not visible due to its ventral location
- Hard ticks also have a dorsal surface shield (the scutum) which is not found on soft ticks.
Life Cycle Notes / Epidemiology
Ticks are temporary ectoparasites whose life cycle consists of four separate stages. (egg, larva, nymph, adult)
- Tick eggs hatch and develop on the ground where motile larvae emerge to migrate to such places as blades of grass or twigs
- These larvae will attach to the first viable host that passes by
- Once on the host, the larva feed via a blood meal for a few days, fall to the ground, and molt into nymphs.
- The eight-legged nymphs then migrate to places where they again wait for another host.
- Once on this second host, the nymphs repeat the cycle, fall to the ground, molt, and develop into adult ticks
Difference in hard and soft ticks in the third host:
Hard ticks (Ixodid family in particular) only feed once as adults.
Soft ticks feed repeatedly as adults.
Following mating, eggs are deposited on the ground and the cycle repeats itself.
- Ticks are found world-wide and are responsible for transmitting Babesia, viral, rickettsial, and bacterial diseases.
Clinical Aspects
Patients infected with ticks may exhibit skin reactions at the site of the bite (inflammation, edema, local hyperemia, hemorrhage)
- Potentially severe tissue reactions & secondary infections may occur when mouthparts remain in the skin after removal of the tick.
- Tick paralysis (tick toxicosis) can occur when the salivary secretions of certain ticks are introduced into the host. (toxins in tick saliva)
Recommended removal of ticks by applying ether or chloroform and pulling the tick straight out of the skin with forceps.
Control measures: avoidance of tick infested areas, protective clothing and tick repellants.
- Prophylactic vaccination to help protect from serious rickettsial infections transmitted by ticks.
Fleas
Fleas are from 1.3 to 4mm long and have three pairs of powerful hairy legs and clawlike feet
- Rear legs are extra long and designed for jumping
- They have compact segmented bodies which enable them to migrate through the hairs or feathers of their hosts.
Mouthparts are designed for both piercing and blood sucking
- Species identification is based on presence or absence of eyes, genal ctenidia, pronotal ctenidia, etc.
- Fleas are visible to the naked eye but microscopic examination is required for species identification.
Life Cycle Notes / Epidemiology
Fleas are found world-wide, over 2500 described species.
- Responsible for transmitting a number of parasitic, rickettsial, and bacterial diseases.
● Developing and adult fleas in between feedings may be found on carpets, rugs, floors, pillows, & other household articles associated with dogs and cats.
Most fleas are ectoparasites of mammals
- Flea eggs are deposited onto the ground by the female adult following mating and feeding via a blood meal.
Legless, elongated larva emerge following a 3-10 day incubation period.
- Incubation period varies with temperature and humidity
● Larvae feed on organic debris as well on adult flea excrement containing dried blood.
● Three larval stages follow with the third-stage larva spinning a cocoon where they remain in a pupa stage for up to one year.
● Adult fleas emerge from the cocoon and may survive for up to one year.
● It is the adult form that may serve as ectoparasites on humans.
Clinical Aspects
Some patients are asymptomatic, others may experience intense itching, dermatitis, ulcerations, nodular swellings at the bite site.
- Scratching may lead to secondary bacterial infections.
Treatment of choice: remove fleas aseptically with a needle
Prevention and control measures: protecting dogs and cats by use of flea collars, powders, dips, sprays, etc
- Lufenuron as a monthly flea prevention medication
- Disinfection of household articles, chemical treatment of known flea breeding areas.
Flies
All flies have two pair of wings, head, thorax, abdomen appear as separate sections. (abdomen is segmented), one pair of antennae, one pair of eyes, most have three pairs of legs.
Life Cycle Notes / Epidemiology
Flies typically undergo complete metamorphosis
- Fly larva emerge from eggs, and the larvae go through several developmental stages.
- pupal stage prior to developing into an adult
Life cycles vary from one species to another
The Tsetse fly, Sandfly, Black fly, and Deer fly are all vectors of important parasitic diseases.
- In most cases, the geographic distribution of the parasitic diseases is dependant on the presence of the specific fly vector.
Sx
Relatively few symptoms are associated with the actual bite of the fly itself. (pain, local inflammation, etc.)
- Myiasis: infestation with fly larvae (maggots)
- Accidental myiasis: having no requirement for development in animal tissue. (housefly; Musca domestica)
- Facultative myiasis: ordinarily feed on dead & decaying tissues in animals. (blowflies & fleshflies)
- Obligatory myiasis: species with an obligate need to invade living tissue. (Dermatobia hominis, the human Botfly)
Lice
Head & body lice are wingless ectoparasites that have a head, thorax, and abdomen, three pairs of legs with clawlike feet.
- They have a single pair of antennae and the mouthparts are adapted for piercing human skin and sucking blood.
- Head louse: Pediculus humanus capitis
- Body louse: Pediculus humanus humanus
- Crab louse: Phthiris pubis
Head & body louse are hairless, 2-3mm long, narrow body
Crab louse is smaller, 2mm long, plump body, covered with hair, thorax & abdomen appear as one section.
Lice are visible with the naked eye but confirmation of identification is normally done microscopically.
Adult lice lay their eggs (nits) on or very near their respective specific hosts. (at the site of infestation)
- Within 24-27 days, the eggs pass through three nymph stages and transform into adult lice.
- The adult lice live only about 30 days
● Lice are found world-wide particularly in areas of poor personal and general hygiene
Transmission is direct, person to person
Crab lice are primarily transmitted via sexual contact
Sx
Infestation with lice is called Pediculosis
Produce itchy papules at infestation site and local hypersensitivity
- Lice saliva and lice excrement result in local inflammation
- Secondary bacterial infections cause a mange-like lesion
Also, rickettsial diseases such as Typhus & Trench Fever as well as spirochete diseases (Relapsing Fever) are associated with lice.
Tx
Successful treatment must destroy both eggs and adults.
Treatment of choice: benzene hexachloride lotion
Prevention & control: proper personal & general hygiene, prompt treatment of known cases, complete and thorough cleaning of all articles an infected person may have come in contact with.
Mosquitos
Over 3,000 described species of mosquitoes
- Have a typical 3-segmented body (head, thorax, abdomen)
- Head is round & connected to body by slender neck
- Abdomen elongate and comprised of 10 segments (8 visible)
Antennae are long and segmented (three segments)
Three pairs of legs and two pairs of wings
Adult mosquitoes lay their eggs in water or in moist places
- Young larvae hatch out of the eggs after a species specific incubation period.
- larvae develop through four distinct stages and eventually form the pupal form.
- The pupa matures further and eventually an adult mosquito emerges.
- Adult mosquitoes are ectoparasites that feed on humans via a blood meal
Sx: itching & inflammation
- Most important symptoms are related to specific diseases that may be acquired
Mites
Tiny arachnids with a fused cephalothorax and abdomen
- Larva have six legs / adults & nmyphs have eight
- Mites are medically important pests that may attack humans directly or act as obligate or facultative parasites
- Certain species act as reservoirs and vectors for infectious diseases
- Mites have been implicated in cases of dermatitis and dust allergies
Delusions of mite infestations (delusory parasitosis) are not uncommon
Hypersensitivity to the mites or their waste products is common
Sarcoptes scabiei
Common name is the itch mite
- Lives in the upper layers of the epidermis where it creates serpiginous burrows under the skin
- Obligate human parasite that causes inflammation and intense pruritis
- Infect interdigital folds but may involve wrists, breasts, buttocks, and external genitalia
- Immunocompromised may develop crusted or Norwegian scabies which is a generalized dermatitis characterized by the presence of thousands of mites
Dx: Finding mite and eggs in skin scrapings
Tx Several options available
Demodex folliculorum
Common name is the follicle mite
- Seen in the hair follicles and sebaceous glands of the face, nose and eyelids, and forehead
- May be associated with acne, comedones (blackheads) or localized keratitis.
- rarely requires treatment
Hymenoptera
Insects such as bees, wasps, and ants inflict a painful sting but generally do not produce any further damage
- Death due to these stings are rare and most of these are the result of senitization to venom (particularly hypersensitivity to bee venom)
- Africanized honey bees → extremely aggressive behavior especially when the hive is threatened (range is expanding rapidly)
Imported fire ants are also very aggressive
- Solenopsis richteri & S. invicta were introduced into the U.S. in 1918 and 1940 and have spread across the southern states
Sx: painful flares and wheals which followed by fluid-filled vesicles that become purulent after 24 hrs.
● Fire ant venom contains a necrotizing toxin and 16% of patients develop a hypersensitivity
Spider Bites
Lactrodectus spp.(Black Widow Spider) is probably the most notorious of all spiders in the U.S.
- venom is highly virulent but the spider is rather timid and has no instinct to bite humans
- Reactions to bites varies
- Hospitalization advisable, muscle spasms may be severe and may require IV muscle relaxants
- antivenom is available and valuable if given early
Spiders of the genus Loxosceles , commonly
known as the brown recluse spider, violin spider, fiddleback spider cause necrotizing skin lesions
- have relatively long legs, and a brown body 5-10mm
long with an inverted fiddle-shaped marking
- bite is fairly painless but mild to severe pain develops within a few hours as well as erythema, vesicle formation, and itching followed by chills, headache, nausea, and other generalized sx
- The bite of Loxosceles spp. may result in kidney damage and death
- initial lesion ulcerates, becomes necrotic, and unless promptly treated does not heal but continues to spread for weeks or months
Tx: Conservative (rest, hydration, cleaning bite, etc.)
- Bites should not be debrided or excised for the first 3-6 wks. but those that have failed to heal in 6-8 wks. may require excision and skin grafting.
Lepidopterism
The hairs of some butterflies and moths can secrete substances that cause dermatitis
Sx: itching, dermatitis, erythema, pruritis, papules, swelling, induration, rash lasting several days
- Epidemic forms in South America during certain months when specific types of moths found
Hylesia alinda moths in two outbreaks of dermatitis among hotel workers in Cozumel Mexico in 1989-90
Erucism
Caused by contact with poison hairs of caterpillars
- Cases described in Louisiana involving Hemilevca maia (buck moth caterpillars)
Sx: erythema, swelling, burning , and itching,
- Occasionally, nausea & fever but symptoms disappear after 24 hrs.
Millipedes and Centipedes
Millipedes do not have a stinger but certain can cause irritation to humans due to chemicals released when crushed
- Centipede Envenomation
- Centipedes can vary in size and severity of sting depending on the species
- They inject venom using a pair of modified legs located near the head
- They become aggressive when cornered, disturbed or mishandled
- Most stings seen in children trying to pick them up
- Many cases involve rolling over on top of the centipede in bed
- The sting is quite painful and comparable to that of a wasp or hornet
Bed Bugs
MC spp Cimex lectularius (cosmopolitan) and Cimex hemipterus (mostly in tropics)
- have piercing-sucking mouthparts
Sx: inflam



Fleas

Crab louse


Adult female louse


Chigger mite

Sarcoptes scabei

Black widow bite

Brown recluse


Bed bugs
Cestodes
Tapeworms are long, flat, ribbon-like worms
- All are hermaphroditic
- do not have a mouth nor a digestive tract; they absorb all nutrients and secrete waste through the tegument (external surface)
All have 3 basic body parts:
1. Scolex - Anterior end of the tapeworm; causes attachment to intestinal wall of a host by means of suckers (4 cup-shaped suckers) and hooks (circular row/s of hooks called a rostellum [elongate protrusible thing in center of scolex] aids in
attachment in addition to the suckers)
2. Strobila - entire body of an adult tapeworm
- Segments formed by budding from the posterior end of scolex, an area of germinal tissue
3. Proglottid - one of the segments of a tapeworm
- Each proglottid contains male and female reproductive organs when mature
- Immature proglottid (no reproductive organs)
- Mature proglottid (see reproductive organs)
- Gravid proglottid (proglottid filled with eggs)
Development
Eggs - embryo seen in certain tapeworm eggs
- called the onchosphere or hexacanth embryo when bears six tiny hooklets, which facilitate entry of the embryo into the intestinal mucosa of the intermediate host (oncho = hook)
Larval Stages in Cestodes
Coracidium: A ciliated hexacanth embryo
- D. latum eggs develop to this stage and hatch in fresh water.
Cysticercoid: The larval stage of some tapeworms (H. nana). A small, bladder like structure containing little or no fluid in which the scolex is enclosed.
Cysticercus: A thin-walled, fluid-filled, bladderlike cyst that encloses a scolex
- Also termed a "bladder worm" (Taenia spp).
Plerocercoid: The larval stage in the development of D.latum that develops after the procercoid stage is ingested by a freshwater fish. This form has an immature scolex and is infective if eaten by
humans.
Dx - Feces examined for the presence of eggs
- Occasionally, gravid Proglottids may be seen
- Rarely a Scolex may be recovered (following treatment)
- Biopsy material may be examined for Echinococcus granulosus
Taenia saginata (Beef tapeworm)
Caused by taeniasis, eating raw / undercooked beef (intermediate host)
Human is only definitive host
Frequently seen in US
Can grow up to 26 meters, usually around 13, usually asymptomatic
Infective Stage: Cysticercus (eggs not infective in humans)
Diagnostic Stage: Eggs in stool (identical to T solium) c thick striated wall and 3 pairs of hooks; - Differentiate from T solium by finding adult gravid proglottids (rarely seen, has >13 lateral uterine branches) or scolex (has 4 suckers) and smooth surface (unarmed rostellum)
Taenia solium (Pork tapeworm)
Caused by taeniasis and cysticercosis, eating raw / undercooked pork (intermediate host)
Human is only definitive host
Seen mostly in immigrants
May grow to several meters, usually asymptomatic
Infective Stage: Cysticercus (encysted organisms)
- eating larval cysts (cysticerci) in undercooked pork causes intestinal tapeworms to grow, but does NOT cause cysticercosis
- eating eggs in food/water causes larvae to hatch that invade gut wall and disseminate, causing cysticercosis
Dx: Eggs (identical to T saginatum); gravid proglottids (rarely seen, has <13 lateral uterine branches), scolex (has 4 suckers and multiple tiny hair-like hooks [armed rostellum])
Cysticercosis: common larval stage known as a cysticercus or bladder worm , caused by eating eggs, results in finding cysts c larvae in brain
- T. solium cysticercoid larva in human tissue
- Man accidentally ingests egg(s), released from proglottid of adult in human intestine which then hatches and matures into the cysticercoid larva
-- thus man is the intermediate host
Sx - Skin - swelling; eye - pain and other symptoms; brain - seizures and/or other neurologic symptoms.
Tx: Praziquantel, paramomycin, quinacrine
Hymenolepis nana (Dwarf tapeworm)
Most common human tapeworm in the US, especially in the Southeast
Definitive Host: Man & Rodents
- Eggs in feces from infected mice and rats in water and food are a common source of human infection.
Intermediate Host: None (Fleas/beetles can serve as transport hosts)
- Cysticercoid larvae can develop in the body cavity of these insects and are infective to either humans or rodents if accidentally ingested
Infective and diagnostic Stages: Egg c inner and outer shell c space in between (inner c 2 polar bow-like thickenings)
4-8 polar filaments, 3 pairs hooklets
Hymenolepis diminuta (Rat Tapeworm)
Definitive Host: Rat and Man
Intermediate Host: Grain beetles, fleas
- cysticercoid larva develop in intermediate hosts
Infective and diagnostic Stage: Egg
No polar filaments; 3 pairs of hooklets; hexacanth embryo
- rat droppings source of infx to intermediate host
Human infx considered accidental zoonotic occurence
Diphyllobothrium latum (fish tapeworm)
Common where freshwater fish eaten raw
- Common in Finnish people and the Baltic region
- A variety of fish-eating mammals can serve as definitive hosts, in addition to humans.
Definitive Host: Man / other fish-eating mammals
Intermediate Hosts: 1. Copepod (Procercoid, Cyclops spp.)
2. Freshwater fish (Plerocercoid, eat infected copepod with procercoid)
Infective Stage: Plerocercoid larva
Diagnostic Stage: Eggs (undeveloped embryo)
- only cestode with operculated egg (which is unshouldered) and has small abopercular knob
Proglottid: Wider than long. Genital pore in center, uterus coiled in rosette pattern
Scolex: Almond structure with two grooves (diagnostic). No true suckers.
- must embryonate in water
Sx
Intestinal obstruction (adult can grow to 20 m)
- Most have vague digestive symptoms, weight loss and weakness.
Can cause macrocytic anemia from B12 deficiency
- Feces must be screened after drug treatment to assure passage of the scolex so that no new proglottids will be formed.
Dipylidium Caninum (Dog/Cat tapeworm, Pumpkin seed tapeworm)
Definitive Host: Dogs & Cats (Humans)
Intermediate Host: Dog and Cat fleas
Infective Stage: Cysticercoid larva within infected fleas
Diagnostic Stage: Proglottids (look like pumpkin seeds c double genital pore) or egg packets
Eggs of D. caninum form membrane-bound packets containing from 5 to 30 eggs each.
- D. caninum is a parasite of dogs & cats but humans can be accidentally infected by ingesting infected intermediate hosts (fleas)
- Intestinal infection follows human ingestion of the larval stage .
- Resulting adult worm self-fertilizes and egg packets (in membrane) & gravid proglottids may be passed in the stool or migrate out anus
- To continue the life cycle, the eggs must be ingested by a flea where larval development occurs.
- Children are primarily at risk for infection transmission.
Echinococcus granulosus (Hydatid tapeworm)
Definitive Host: (Herd) dogs / wolves
Intermediate Host: Human, Sheep (herbivores)
Infective Stage: Eggs
Diagnostic Stage: Hydatid cyst
Echinococcus multilocularis has sheep, mice squirrels and voles as intermed hosts and humans as accidental hosts
Cyst can be found in the liver (most commonly) or lung of man. Lung symptoms include coughing and pain. Leakage of hydatid fluid causes allergy and eosinophilia
Man ingests eggs. The eggs hatch, hexacanth embryo migrates to tissue (liver, lung, or other organs) develops into hydatid cyst
- Hydatid cyst: vesicular structure that contains fluid, brood capsules, and also daughter cysts in which the scolices of potential tapeworms are formed (protoscolices) - also agglutinates P1 ag
- Hydatid sand: Granular material consisting of free scolices, hooklets, daughter cysts, and amorphous material. Found in the fluid of older cysts of E. granulosus
- Human infections are found primarily in sheep-raising areas where domestic dogs are used in herding
- the P ag can be agglutinated by hyatid cyst fluid and pigeon eggs
- Eggs ingested by a herbivore and then infected viscera eaten by a canine (dog), the cysts would break open in the intestine of the dog and each scolex in the cyst would develop into an adult tapeworm
Dx: ELISA, Western blot, indirect hemagglutinatio
Tx: Surgery
Sparganosis
Infection of humans by plerocercoid larvae of various diphyllobothroid tapeworms belonging to the genus Spirometra
- Man is an acceptable second intermediate host for certain species that normally develop to the adult stage in other mammals
Infection acquired by drinking water containing copepods infected with the procercoid larval stage
- The larva penetrates the gut wall and works it’s way into the muscles or subcutaneous tissues where it grows into the Sparganum larva.
- These larva may migrate actively in the subcutanouse tissues
- Snakes or tadpoles may be consumed raw for medicinal reasons and may be infected with plerocercoid, capable of penetrating the intestinal wall of humans
- In some areas of the world, poultices of frog or snake flesh is placed on open wounds or other lesions, especially of the eyes.
- If the material is infected with plerocercoid larvae, these may actively penetrate into the poulticed lesion
- Ocular sparganosis acquired in this manner is not- uncommon in China or Vietnam
Characteristics of the Sparganum
Anterior end capable of invagination and may resemble the sucking grooves of the mature scolex.
Sparganum proliferum - peculiar budding type of larva that may occur anywhere in the body
- May break into segments capable of further independent development
- These infections are extremely serious
Sx
Early migratory stages are asymptomatic
- After reaching it’s final site, it elicits a painful inflammatory reaction in the surrounding tissues
- Ocular sparganosis produces an especially intense reaction with periorbital edema
- Lids may not close, corneal ulcers, etc.
- Cerebral sparganosis - seizures, paresthesias, hemiparesis, and similar CNS symptoms
Tx: Surgical removal when present in small numbers & Praziquantel
- Avoidance of drinking water from ditches & ponds
- Avoidance of using potentially infected animals for medicinal purposes
Coenurus disease
Larval stage of Multicepts multiceps known as coenurus
- a taeniid tapeworm of dogs
- sheep MC intermediate host (dz known as gid in sheep)
- when humans ingest the eggs, they develop into tapeworm larvae that group in cysts known as coenuri
- eggs mature into larvae but not adult worms
- embryo travels to brain or spinal cord, forming a bladder worm, and gives sx similar to cysticercosis


Taenia scolex
Taenia egg


Hymenolepis nana egg
D latum egg

D latum proglottid

D latum scolex, with 2 grooves, no true suckers


Dipylidium caninum scolex

Dipylidium canum proglottid


Trematodes
*** Marilyn Manson has the weird crooked spine ***
Flukes in the class Digenea are bilaterally symmetrical along a longitudinal axis, are flattened dorsoventrally, are usually leaf-shaped
- Bilateral excretory system ending internally in solenocytes (flame cells)
- Vary in size from a few mm to several cm in length
- Adult flukes have two cup-shaped muscular suckers (acetabula)
a) Hermaphroditic Flukes
- Have both sets of highly branched reproductive organs
- Live in the intestine & other organs of definitive host
b) Dioecious Flukes
- Live as unisexual adult pairs, male and female, in the blood vessels of the definitive host.
- Schistosomes (blood flukes)
Larval Forms
Miracidium; ciliated form, morphology varies according to species
Cercaria; free-living tailed form
Metacercaria; as soon as cercaria loses its tail
Eggs are the diagnostic stage
Size and morphology vary depending on species
Life Cycles
Flukes have complex life cycles that involve snails as first intermediate hosts
- Many also utilize a second intermediate host (most frequently fish)
- Specific freshwater molluscs are infected by a ciliated larva (miracidium)
- A complex developmental process occurs within the intermediate host
Tailed larva (cercaria) are released from the snail into water
- Cercaria may infect humans directly (schistosomes) or more commonly invade the tissues of a second intermediate host
- Some metacercariae (infective stage) encyst on various types of aquatic vegetation
Human infection is acquired by ingestion of infective stages (exception - schistosomes)
- Adults develop in the definitive host (man) and produce eggs
- Trematode infections are diagnosed by identification of eggs in feces, or more rarely, in sputum or urine
Eggs of all human trematodes except schistosomes have an operculum through which the miracidium escapes
- Small trematode eggs usually contain a fully developed miracidium when passed in the in the feces (as do the schistosome eggs)
- Larger trematode eggs are undeveloped when passed
INTESTINAL FLUKES
Fasciolopsis buski (large intestinal fluke)
Largest and most pathogenic of the human intestinal flukes
- Asia, Southwestern Pacific, China, India, Indonesia, Taiwan, Thailand, Vietnam
- Pigs and humans are the primary hosts
- Acquired by ingestion of aquatic vegetation upon which metacercaria are encysted
- Adults reside in the small intestine and may produce severe toxic symptoms in large numbers
Eggs are large (130-140μm x 80-85μm), oval, unembryonated when passed in feces
- Operculum is not conspicuous, shell is relatively thin at abopercular end
- Fasciolopsis buski eggs are indistinquishable from those of Fasciola hepatica
Dx: may depend on sx and geographic history
Sx; mucosal ulcers, pain, nausea, mucous diarrhea, anemia, intestinal obstruction, malabsorption, generalized edema, marked eosinophilia........can be fatal
Heterophyid Infections (Heterophyid Flukes)
Numerous species of minute intestinal flukes parasitize humans throughout the world
- Usually of little medical importance but eggs may resemble those of certain liver flukes (Clonorchis sinensis and Opistorchis felineus)
1. Heterophyes heterophyes: Asia, Egypt, Turkey
2. Metagonimus yokogawai: Asia, Balkan states
- All the heterophyids show little host specificity
- Dogs, cats, various wild animals are the usual definitive hosts in nature
- Adult flukes live in the crypts of the small intestine & are only a few mm long
Acquired by ingestion of improperly cooked fish harboring the metacercariae under their scales
- Usually little or no symptomology but when large numbers of organisms are present, patient may have mild chronic mucous diarrhea and abdominal cramping
- All heterophyid eggs are small (20-30μm x 13-17μm), ovoid, with inconspicuous operculum
Eggs contain a miracidium when laid
- Though similar to Clonorchis eggs, heterophyid eggs do not have a seated operculum
- Eggs are usually passed in small numbers and infections are self- limiting
LIVER FLUKES
Fasciola hepatica (Sheep Liver Fluke)
Worldwide distribution in sheep and cattle raising areas where it occasional causes human infection.
- Relatively uncommon in the U.S.
- Acquired by ingestion of aquatic vegetation on which metacercariae have encysted
- Ingestion of infected sheep or cattle liver may result in transient passage of eggs in feces
- Human infx is a zoonotic disease since sheep are the natural definitive hosts
Metacercariae migrate from intestine to the bile ducts of the liver
- Worm can also goto body wall, cutaneous tissues
Adult worms are large fleshy flukes that may cause severe liver damage
Sx; fever, hepatomegaly, eosinophilia in endemic areas, jaundice, bile duct obstruction (from fibrosis), diarrhea, anemia, pruritis, uticaria, cough, etc.
Dx: Eggs are large (130-150μm x 63-90μm), ovoid, and have a yellow- brown shell and have an inconspicuous operculum & are unembryonated when deposited (looks kinda like a door and is identical to F buskii)
- adult is flat with a cephalic cone (distinguishing feature from F buskii)
Clonorchis sinensis (Chinese or Oriental Liver Fluke)
Found in the Far East, especially Southern China and South East Asia
Adults live in the bile ducts of humans and reservoir host animals including dogs & cats
- Infection acquired by ingestion of metacercariae on the scales of freshwater fish
Sx; jaundice, hepatomegaly, abdominal pain, diarrhea, anorexia, etc.
- Infections may persist for 20 yrs. or longer
- light infections may be asymptomatic
- Chronic cases with heavy worm burden may induce biliary fibrosis and cholangiocarcinoma
Dx: Embryonated eggs are small (27-35μm x 12-19μm), oval shaped, and have a yellow-brown moderately thick shell with a seated/shouldered operculum
- A small knob is usually present at the abopercular end
- adult has snout-like cephalad
The genus Opisthorchis has similar life cycle, pathology, intermediate and definitive hosts, as well as similar adult morphology
- Clonorchis and Opistorchis eggs are similar in size & appearance to heterophyid eggs but can be differentiated by the presence of a knob and a seated operculum
LUNG FLUKES
Paragonimus westermani (Oriental Lung Fluke)
Found in the Asia
- dogs & cats, and wild animals serve as reservoirs
- Adult flukes usually live in a fibrous capsule in the lung parenchyma
- Eggs that are produced pass up the bronchial tree and may be found in sputum or in feces after they have been swallowed
- Crabs and crayfish are second intermediate hosts
- Humans acquire infection eating raw or undercooked infected crustaceans
- In the human host, metacercariae migrate from the intestine into the body cavity through the diaphragm and invade the lungs
- In the course of larval migration, the organisms may take aberrant routes and end up in ectopic locations (body wall, ribcage, brain - often fatal when in the brain)
- Infections may be long-lived and last 10 - 20 yrs.
Sx; chronic chest pain, cough, blood-tinged sputum (rust colored), lung infiltration, nodules, abcesses
- Adults are found in fibrous cysts (often in pairs) and eggs pass through the cysts and rupture into bronchioles
Dx: Chest X-ray may resemble tuberculosis
- Diagnosis dependent on finding eggs in feces or less frequently in sputum
- Eggs are broadly ovoid with a thick yellow-brown shell and a distinct operculum and shoulders
- Large (80-120μm x 45-70μm) and unembryonated
- Abopercular end is distinctly thickened but there is no knob
Paragonimus kellicotti
Causes infx in N America
Lung flukes c complex life cycle, needing snail and crustacean intermediate hosts
- definitive hosts excrete eggs in feces or sputum
- eggs hatch in H2O and become ciliated miracidia, which then invade ST of snails where they reproduce asexually
- cercariae coming from snails inbade a secondary intermiate host, crustaceans
- human infx rare (mostly in southerners eatin raw crayfish
Sx: cough, fever, eosinophilia
Dx: Difficult (eggs rarely seen in poo or spit)
Tx: praziquantel
BLOOD FLUKES (Schistosomes)
General Information
Schistosomiasis or bilharziasis (Swamp Fever) is one of the most important parasitic diseases
- all must pass through freshwater snails
Kayatama Fever = systemic hypersensitivity rxn to schistosoma in tissue (in acute infx) caused by circulating immune complexes
Adult worms have separate sexes and live as pairs in the blood vessels of the abdominal cavity (Dioecious)
- Eggs are thin-shelled with no operculum and contain a miracidium when passed in poo, or peepee (S hematobium)
- Infected snails produce fork-tailed cercariae which directly penetrate the skin and establish infection in humans and animal hosts
- Once inside the body they migrate to the venous blood vessels of the mesenteries or the bladder where they mature and females deposit their eggs
- Through a poorly understood mechanism, eggs go through the intestinal or bladder wall and pass into feces or urine
- Disease primarily b/c of egg deposition in tissue at the site of adult worms or the areas of venous drainage. (liver or lung)
Schistosoma mansoni (Manson's Blood Fluke)
Wide geographical range; Africa (esp the Nile Delta), Middle East, South America, Carribean, West Indies
- Adult worms live in the portal system of the liver and small venules of the inferior mesentery
- Eggs deposited in the blood vessels go through the intestine wall to be passed in feces
Dx: Eggs large (114-175μm x 45-70μm) c miracidium
- The shell has a prominent lateral spine
Acute schistosomiasis, blood and mucous appear in feces along with the eggs
Chronic schistosomiasis, eggs will accumulate in the walls of the intestine, liver and rectum
- chronic has fewer eggs in feces and concentration procedures will be required
Sx; first reaction is dermatitis, acute phase may resemble typhoid, fever, cough, myalgias, malaise, hepatosplenomegaly, pipestem fibrosis, cirrhosis, bloody diarrhea, bowel obstruction, hypertension, etc.
- Toxic reactions may be present due to granuloma formation
Schistosoma japonicum (Oriental Blood Fluke)
Found in China, Phillipines, other countries of S.E. Asia
- Animal reservoirs are important and include water buffalo, pigs, dogs, cats, and wild rodents
- Adult worms live in the mesenteric veins and liver
Sx; same as for S. mansoni but may be more severe due to greater egg production
Dx: Eggs in feces (70-100μm x 55-65μm) are embryonated, oval and lack an operculum
- The thin shell has a small inconspicuous spine The surface of the egg often covered with fecal debris, making it difficult to observe or recognize
Schistosoma haematobium (Bladder Fluke)
Found in Africa, Middle East, and Portugal
- Adult worms reside in the venous plexus of the bladder, causing urinary schistosomiasis
- Eggs go through bladder wall and pass in urine
Sx; bladder colic with hematuria and pus in urine, also mild systemic symptoms
- In chronic infections, accumulation of eggs in the bladder wall can lead to bladder and ureter SCC
Dx: thin-shelled eggs (112-170μm x 40-70μm), embryonated, c a terminal spine
- Hematuria is frequently present and diagnosis is made by finding eggs in urine sediment (best collected during the day after exercise)
- Eggs can sometimes be found in feces and in the wall of the rectum and bladder
- Schistosoma intercalatum also has eggs with a terminal spine, but are bigger, and in feces
Schistosome Dermatitis (Swimmer's Itch)
Schistosome dermatitis is found world-wide, including Southern California and the San Francisco bay area
- Cercariae of certain non-human blood flukes can cause an aggravating form of dermatitis
- Forked tailed cercariae of schistosomes that parasitize birds (ducks, geese, waterfowl) as well as mammals, burrow into the skin of humans swimming or working in water
- It is probable that cercariae of mammalian and avian schistosomes are all capable of penetrating the skin of man
Sx; initial prickling or nettling sensation which subsides leaving a macule at each site of penetration
- In a few hrs. an intense itching occurs and the macules transform into papules
- Reaction reaches it's maximum between the second & third day, then gradually decreases
- This is an allergic dermal response
- These schistosomes do not develop into adults in humans
Trematode eggs


Fasciolopsis buski

Fasciolopsis buski adult ---------------->
Metagonimus yokogawai adult fluke

Large Fasciola hepatica egg


Small Clonorchis sinensis eggs


C Sinensis adult


Paragonimus westermani egg




Schistosoma eggs

Schistosomes


Severe HSmegaly in S. Mansoni

S Mansoni egg c lateral spine

S mansoni egg in intestine wall

S japonicum egg

S hematobium eggs

S dermatitis



References
1. LLU notes
